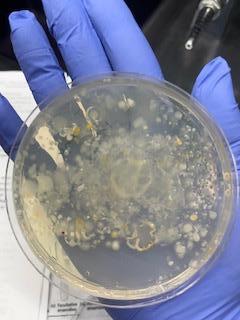
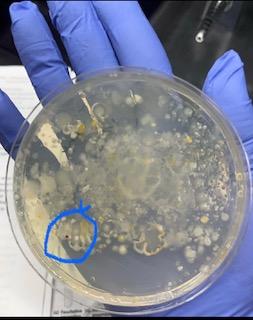
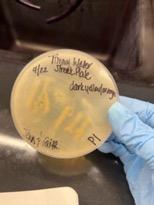
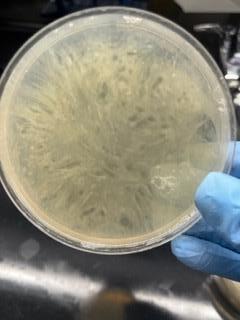
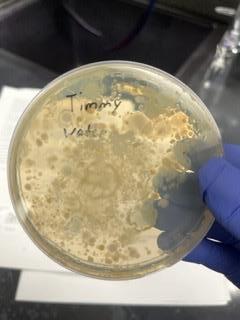
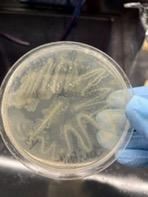
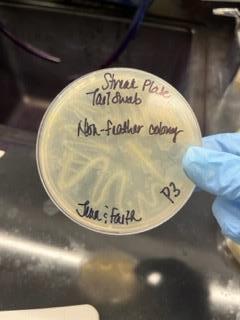
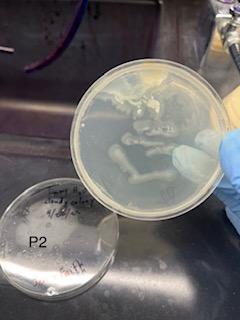
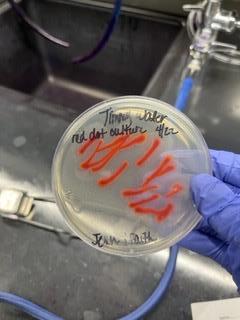
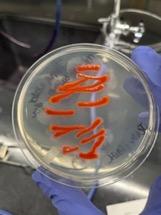
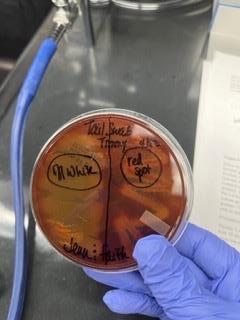
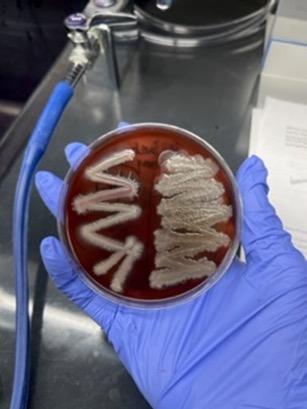
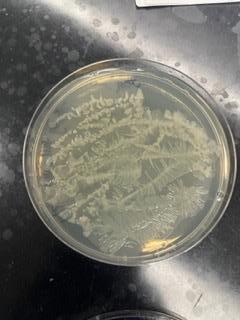

The Oak Leaf is a peer-reviewed, open-source, multidisciplinary student research journal.
The Oak Leaf is a part of CORE at LSUA.
Center for Opportunity, Research, and Experiential Learning
Louisiana State University of Alexandria


8100 Hwy 71 South
Alexandria, LA 71302
ISSN: 2691-6495
https://www.lsua.edu/the-oak-leaf
Copyright © 2022 Louisiana State University of Alexandria
The Oak Leaf is licensed under a Creative Commons Attribution-NonCommercial-NoDerivs License (CC BY-NC-ND) by Louisiana State University of Alexandria. This license allows reusers to copy and distribute the material in any medium or format in unadapted form only, for noncommercial purposes only, and only so long as attribution is given to the creator.
The Oak Leaf | Volume 3 - Issue 1 - Spring 2022
The Oak Leaf Editorial Board
Editor-in-Chief Christof Stumpf
Louisiana State University of Alexandria
Managing Editor Alice Blackwell for the Humanities
Louisiana State University of Alexandria
Managing Editor Sarah Barnes for Health and Human Services
Louisiana State University of Alexandria
Managing Editor Zebulon Bell for the Social Sciences
Louisiana State University of Alexandria
Managing Editor Purujit Gurjar for the Natural Sciences
Louisiana State University of Alexandria
Book Review Editor Alice Blackwell
Louisiana State University of Alexandria
The Oak Leaf | Volume 3 - Issue 1 - Spring 2022 3
Letter from the Editor

This is now the third year since The Oak Leaf appeared for the first time. I would like to thank Ginger Jones for her stewardship through the initial years of our beloved publication. I cannot express Dr. Jones’ contributions better than simply citing our own website:
Her notable contributions included renaming and rebranding the journal, designing a new website, earning a National and Louisiana Endowment for the Humanities Grant to publish the journal, expanding the interdisciplinary scope of the journal, and building partnerships with the campus and Rapides Parish libraries.
Changes enacted at The Oak Leaf this year are meant to make managing the publication easier, increase its reach, and spell out rules more clearly. The new Editorial Board consists of the Editor-in-Chief (Christof Stumpf), the Book Review Editor (Alice Blackwell), the Managing Editor for the Humanities (also Alice Blackwell), the Managing Editor for Health and Human Services (Sarah Barnes), the Managing Editor for the Social Sciences (Zebulon Bell), and the Managing Editor for the Natural Sciences (Purujit Gurjar). This move brings The Oak Leaf in line with most major publications. Faculty members are now mentors for their students and not co-authors of their students’ publications. This change strengthens the role of students in publishing their own work. In order to avoid different citation styles for similar types of publications by different authors, we enacted rules on acceptable styles: MLA style for the humanities, APA style for psychology, Chicago style for history, and CSE style for the natural sciences. More citation style rules are yet to follow. Each volume of The Oak Leaf will be published in two electronic issues per academic year, one in fall and one in spring, and each volume will also appear in print at the end of the academic year. Future endeavors to increase the number of submissions and of potential reviewers include contacting faculty members at LSUA’s peer institutions and at other COPLAC schools and to add a new type of submission called Historical Review as a publication choice for authors.
For the fall issue of The Oak Leaf, five exciting papers have made the deadline. Caitlyn Guidry (mentor: Julie Gill) writes about the benefits and importance of occupational therapy in children; Alicia Lewis (mentors: Sandra Gilliland and Mark Lacour) compares parental stress of homeschool and non-homeschool parents; Jennifer Mathews (mentor: Cheryl Bardales) researches dangers emanating from touching turtles with bare hands; Kane Prestenback (mentor: Brenda Ellington) analyzes meaning, language, woods, and words in Sondheim’s Into the Woods; and Austin Souphanthalop (mentor: Zebulon Bell) investigates sex-addiction in men who have sex with men. Several other fascinating papers only need some finishing touches to be included into the spring issue of The Oak Leaf. The Editorial Board encourages every student to contemplate submitting a manuscript. Talk to your mentor and find out if you have something publishable in your hands. We wish you a great end of the semester and hope to see your manuscript soon.
Christof Stumpf Editor-in-Chief, The Oak Leaf
The Oak Leaf | Volume 3 - Issue 1 - Spring 2022 4
Table of Contents
The Benefits and Importance of Occupational Therapy for Children
Caitlyn E. Guidry
Louisiana State University of Alexandria
Faculty Mentor: Dr. Julie Gill
Parental Stress of Homeschool Parents Vs. Non-Homeschool Parents
Alicia Lewis
Louisiana State University of Alexandria
Faculty Mentors: Dr. Sandra Gilliland and Dr. Mark LaCour
If You Must Touch a Turtle, Wash Your Hands
Jennifer Mathews
Louisiana State University of Alexandria
Faculty Mentor: Dr. Cheryl Bardales
“Careful the Things You Say”: Meaning, Language, Woods, and Words in Sondheim’s Into the Woods
Kane Prestenback
Louisiana State University of Alexandria
Faculty Mentor: Dr. Brenda Ellington
Sex Addiction in Men Who Have Sex with Men
Austin Souphanthalop
Louisiana State University of Alexandria
Faculty Mentor: Dr. Zebulon Bell
The Oak Leaf | Volume 3 - Issue 1 - Spring 2022 5
................... 6 .................... 14 .................... 28 .................... 38 .................... 44
The Benefits and Importance of Occupational Therapy for Children
Caitlyn E. Guidry
Abstract
Child development is key for successful integration into society. Not all children are born with the ability to integrate themselves into everyday life, and these children may require services like occupational therapy. This research paper will address the many benefits of occupational therapy services and why therapy is important in the lives of children from the time they are born up until they are twenty-one. This paper aims to review the skills needed for daily life, the intervention methods used during therapy sessions, and the effectiveness of each intervention method. In addition, the paper uses specific diagnoses that are seen frequently in a therapy setting to further provide evidence of the benefits and importance of occupational therapy services for children. Barriers to therapy services are also discussed throughout the paper along with reasoning behind why elimination of the barriers is important for children living with different disorders.
Keywords: occupational therapy, skill sets, intervention methods, health disparities, social participation
Children of all ages need assistance as they grow and learn. Assistance may come from parents, caregivers, and teachers, but additional assistance may be necessary through the aid of occupational therapists (OTs). Occupational Therapists are equally important in the lives of children who experience neurological disorders. Occupational therapy for children can be extremely beneficial and important so that children with these disorders can reach their full potential and succeed at a higher level (Gouveia, 2018).
According to the American Occupational Therapy Association (2021, c), “occupational therapy is the only profession that helps people do the things they want and need to do through the therapeutic use of daily activities” (para. 2). This form of therapy can be useful for those with disabilities, injuries, and those who simply need support through physical and cognitive changes. Occupational therapy is not limited to one specialty since it is used throughout all stages of the
lifespan. The different specialties that are included in the field of occupational therapy include: gerontology, mental health, pediatrics, physical rehabilitation, driving and community mobility, environmental modification, and feeding, eating, and swallowing. Gerontology and pediatrics are the only two specialties that focus on specific age ranges; gerontology focuses specifically on the older population (Greenwood, n.d.) while pediatrics focuses on the younger population (American Occupational Therapy Association, 2021, a).
Pediatric occupational therapy follows the same concepts as other forms of occupational therapy. This particular specialty focuses exclusively on young children, typically ranging in age from birth to twenty-one years (Breithart, n.d.). Pediatric occupational therapists play a major role in the lives of children as these therapists work with each child individually to help them develop many skills that are important for integration into
The Oak Leaf | Volume 3 - Issue 1 - Spring 2022 6
normal life. These skill sets could include fine motor skills, hand-eye coordination, sensory integration, social skills, and activities of daily living. In addition to these skill sets, pediatric occupational therapists also work with children who have cognitive delays. Therapy sessions with children are often treated as play time in order to keep the child focused. Therapists use motivating activities like puzzles, board games, and crafts to work on physical, cognitive, and social skills (Pathways, 2020).
Each child’s needs are different and therefore require different intervention methods. For instance, some children may struggle with self-care—these children in this scenario may benefit from occupational therapy in order to help the child build confidence within themselves and also learn autonomy (Beisbier & Cahill, 2021). Another area that may require additional help from a therapist could be play and social participation. Play is crucial in the lives of children, as it helps to develop social skills. Occupational therapy settings use play to work on other skills that may assist the child with learning social skills without ever realizing it. Sensory processing disorders cause a child to struggle with adapting and responding to sensory input. Children with these specific disorders usually require occupational therapy since sensory processing disorders often hinder activities of daily living and the ability to interact with others and learn (Pfriffer et al., 2018).
Access to occupational therapy services is important for children who suffer from different disorders. However, health disparities can impede a person’s access to these services. For the purpose of this paper, health disparities are “differences that occur due to social or economic disadvantages” (Dallman et al., 2020, p. 1317). One specific disorder that is more likely to be affected by health disparities is autism spectrum disorder. In the case of autism, racial disparities are common. White children are more likely to receive a diagnosis when compared to African American children, while Hispanic children are least likely to receive a diagnosis at all (Dallman et al., 2020, p. 1317). Similarly, socioeconomic groups also cause disparities. Higher socioeconomic status
families are more likely to receive an earlier diagnosis than those who are of a lower socioeconomic class (Dallman et al., 2020, p. 1317). These disparities lead to the conclusion that not all children who need therapy for autism and other disorders may be able to acquire a diagnosis needed for therapy. Consequently, a child who is deprived of a diagnosis and therapy may not develop all of the basic skills needed to succeed. In short, occupational therapy services for children are crucial in cases of disorders like autism and disparities in health care.
Pediatric occupational therapy is beneficial for children of all ages who have different disorders or cognitive delays. The early stages of a child’s life, specifically, are when social, cognitive, and physical development occurs (Top Occupational Therapy Schools, 2020). Developmental milestones do not always occur as quickly as they should. Children who experience delays can benefit from occupational therapy, as this form of therapy helps to improve cognitive and communication skills and also helps to minimize the developmental delay (Top Occupational Therapy Schools, 2020).
All children need gross motor skills from birth, and this set of skills is one beneficial aspect that may result from occupational therapy. Gross motor skills, according to Chicago Occupational Therapy (2021), involve movement and development of large muscles in the body that are important for “crawling, walking, jumping, and catching a ball” (para. 2). Occupational therapists can help improve these skills, so the child has better posture, stability, and balance (Chicago Occupational Therapy, 2021). Another benefit of occupational therapy in children is the improvement of fine motor skills. These skills involve the muscles of the hands and fingers. Skills like manipulating buttons and writing fall under this category. Occupational therapists can help a child become more independent through the development of fine motor skills. The next benefit of occupational therapy is the improvement of independence when performing activities of daily living. Activities like feeding oneself, dressing, and brushing one’s hair are included in this skillset. Another benefit
The Oak Leaf | Volume 3 - Issue 1 - Spring 2022 7
of occupational therapy is that it addresses sensory processing difficulties. An occupational therapist can assist with sensory processing issues by helping a child “better receive and respond to the sensory input they are receiving” (Chicago Occupational Therapy, 2021, para 5). Examples of how therapists accomplish improving sensory issues could include the introduction of new food textures and new fabrics for the child to learn.
The next benefit of occupational therapy is increasing a child’s overall strength and stability, which are fundamental skills required for everyday life. Strength and stability lay the foundation for fine and visual motor skills and activities (Chicago Occupational Therapy, 2021). Another benefit of occupational therapy is the enhancement of social and play skills. In order for a child’s social and play skills to improve, an occupational therapist may work with multiple children at once to introduce the children to skills like sharing, taking turns, understanding social cues, and expressing emotions (Chicago Occupational Therapy, 2021).
The next benefit of occupational therapy is the improvement of executive functioning skills. These skills include attention, organization, and memory. Occupational therapists can run sessions that work on these skills specifically in order to help a child improve academically and in daily life (Chicago Occupational Therapy, 2021, para. 8). The improvement of strength and stability allow the child to improve both visual perception and visual motor skills. These skills allow a child to write, draw pictures, and to make sense of what they are seeing (Cincinnati Children’s, 2021, paras. 1 & 8). “Visual perception” is an umbrella term for a collection of skills required for interpretation of what a child is examining. Skills included under “visual perception” are visual discrimination, visual memory, form constancy, figure ground, and visual closure (Cincinnati Children’s, 2021, paras. 3-7). Visual motor skills enable coordination of the eyes and hands for drawing and handwriting. Children who have deficiencies in visual perception and visual motor skills may struggle with copying shapes, lining up math problems, and locating objects that are hidden in busy
backgrounds (Cincinnati Children’s, 2021, paras. 6, 8).
Occupational therapy is also beneficial in terms of parent and caregiver education, also known as coaching. Occupational therapists provide education and home programs for parents and caregivers to use outside of the therapy setting. Coaching, in pediatric occupational therapy, focuses more on the parent than the child. Therapists can present information to parents that may help the parent and child outside of the occupational therapy setting. This intervention method assists parents in the recognition and implementation of “social and environmental changes that support more successful performances for themselves and their children” (Graham et al., 2009, para. 1). These learned skills are transferred from the therapy sessions to the child’s home and classroom setting (Chicago Occupational Therapy, 2021).
One final benefit of occupational therapy for children is help with assistive technology. Occupational therapists can help determine if a child would benefit from assistive technology, and they can provide parent and caregiver education for the proper use of the technology (Chicago Occupational Therapy, 2021). Assistive technology and assistive devices work together and include any piece of equipment that aids in helping a person perform an activity or improve an ability (Cerebral Palsy Guidance, 2020, para. 1). One example of a scenario where assistive technology could be beneficial could include a student who struggles with reading and writing tasks because of limited motor control. Occupational therapists can introduce technology options like a word processor with word prediction which assists with writing efficiency and legibility (American Occupational Therapy Association, 2010). Another example could be a college student who uses a power wheelchair and struggles to reach the tables in his or her lab class. An occupational therapist can offer mobility options for the wheelchair that include a standing feature which allows easier access to lab tables and cabinets in the classroom (American Occupational Therapy Association, 2010). Additional examples could include adaptive scissors for cutting paper or a shoehorn to assist a child when they are
The Oak Leaf | Volume 3 - Issue 1 - Spring 2022 8
putting on their shoes. Benefits of assistive technology include improvement of academic performance, a more engaged social life, higher levels of self-confidence, and greater independence (Cerebral Palsy Guidance, 2020, paras. 6, 8, 11-12). Overall, there are a plethora of benefits that come from occupational therapy.
Occupational therapy in children is not only beneficial, but in most cases, therapy is also important. Extremely pre-term infants are at a higher risk of developing neurological disorders and developmental problems. Early occupational therapy intervention has shown better cognitive development and performance later in life (Salokorpi et al., 2002). Another scenario in which occupational therapy is important is when a child does not receive a diagnosis but displays signs of neurological disorders or developmental problems. Fortunately, a diagnosis is not required for therapy services. Case-Smith et al. (2013) state that “delays in developmental milestones alone can qualify [children] for services” (p. 413). There are other reasons why occupational therapy is important outside of pre-term infants and undiagnosed cases. Occupational therapy is important because it helps create a routine in a child’s life and it helps the child with activities of daily living. This could include tasks like brushing teeth, using the restroom, and hygiene. These skills are crucial in a child’s life as they allow the child to be independent. Improving sensory issues is also a contributor to the importance of occupational therapy. Sensory issues lead to a child becoming distracted easily and feeling under sensitized or over sensitized in different situations. Under stimulation or overstimulation may lead to children reacting inappropriately. An introduction into occupational therapy can lead children with sensory processing disorders to learn how to interpret and regulate sensory input so they can participate in daily life (Gouveia, 2018, paras. 6 & 7). One other factor that contributes to the importance of occupational therapy is the improvement of motor development. This is an important skill that is required more frequently as a child grows and develops. Tasks that use a fork or spoon, buttons, zippers, or tying shoelaces are all motor skills. Occupational therapy can help a child develop
these skills at the correct time in order to meet their developmental milestones.
Occupational therapy for children is not only important and beneficial, but it is also effective. Implementation of different intervention methods in occupational therapy can benefit children of all ages. Occupational therapy for children is especially effective in promoting engagement and participation in a child’s daily life roles. These roles can include the development of independence, productivity, and participation in play and leisure activities Novak and Honan (2019). Novak and Honan (2019) tested multiple intervention methods for effectiveness and found that forty of these methods were proven to be effective while all other intervention methods were said to be somewhat effective (p. 5). Intervention methods discussed in the study include stretching, assistive technology and assistive devices, behavioral interventions, bimanual interventions, bimanual training, biofeedback, coaching, cognitive education, and sensory approaches.
Stretching techniques can be used to help children who experience weakness due to injury or illness. Stretching is mainly used to help improve strength and range of motion (Seattle Children’s, 2021, para. 13). Torticollis, a condition that is commonly seen in occupational therapy settings, is defined as the “tightness of the sternocleidomastoid muscle on one side of the head” (Kray, 2017). Stretching of the neck in an occupational therapy clinic focuses on stretching the muscles to condition and strengthening the muscles on the opposite side of the neck. Stretching techniques also help with tightness of the shoulder muscles, an increase in the shoulders’ range of motion in the shoulders, prevention of asymmetries of the face and cranium, positional deformities of the eye and ear, scoliosis, and ocular and visual impairments (Kray, 2017).
Behavioral interventions are particularly effective in occupational therapy and can assist children who struggle to self-regulate their emotions. Additionally, occupational therapy can also use interventions to improve behavior through activities that promote
The Oak Leaf | Volume 3 - Issue 1 - Spring 2022 9
receptive language, expressive language, executive functioning, emotional regulation, social skills, and planning tasks or activities (Kid Sense, 2021, paras. 3139). Behavioral interventions in occupational therapy can include holding sessions focused on organizing the child’s day, setting boundaries and expectations, using behavior modification charts, and rewarding the child for good behavior and completed tasks (Pawar, 2016). Habits and behavior are changed by increasing the frequency of a wanted behavior and decreasing the frequency of an unwanted behavior (Pawar, 2016).
Bimanual interventions/training are especially useful for those children who have movement difficulties in one limb. Bimanual intervention helps children affected by conditions like cerebral palsy to learn how to move and use both arms and/or legs at the same time (Cerebral Palsy Alliance, 2016). Biofeedback can be used in pediatric occupational therapy for many different medical conditions such as pain disorders, anxiety, pelvic floor dysfunction, and eating disorders. According to Stanford Children’s Health (2021), biofeedback is “a treatment modality or tool that can help older children and adolescents learn how to create a calmer state, increase their focus, improve pain management, or improve muscle coordination skills” (para. 14). Cognitive education helps children through the promotion of skill acquisition and also through engagement in meaningful relationships and activities (American Occupational Therapy Association, 2021, b). Finally, sensory approaches help children with sensory processing issues. Sensory approach assists children by introducing different stimulators into the child’s routine to teach them how to learn to regulate the sensory input. Over time, the brain adjusts to the input and the child will be able to adapt and process the sensory input more easily and efficiently (Morin, 2020, para. 1).
Overall, pediatric occupational therapy offers many different intervention methods that have been proven to be effective (Novak & Honan, 2019). Intervention may be beneficial for a multitude of deficits, including cognitive delays, gross and fine motor skills, visual perception and visual motor skills, hand-eye coordination, sensory
integration, social skills, and activities of daily living. Intervention through occupational therapy is also very important and beneficial in the lives of children who struggle with different conditions on a daily basis (Gouveia, 2018). Familiarity with the benefits, importance, and effectiveness of occupational therapy in children can allow for a child to live a better, more successful life.
The Oak Leaf | Volume 3 - Issue 1 - Spring 2022 10
References
American Occupational Therapy Association. (2010). The role of occupational therapy in providing assistive technology devices and services. https://www.aota.org/about-occupational-therapy/professionals/rdp/assistivetechnology.aspx
American Occupational Therapy Association. (2021, a). Children & youth. https://www.aota.org/practice/ children-youth.aspx
American Occupational Therapy Association. (2021, b). Cognitive orientation to daily occupational performance (CO-OP) approach: Evidence-based, occupation-centered intervention for children. https://www.aota.org/ Education-Careers/Continuing-Education/AOTACE/CE-Articles/cognitive-orientation-pediatrics.aspx
American Occupational Therapy Association. (2021, c). What is occupational therapy. https://www.aota.org/ conference-events/otmonth/what-is-ot.aspx
Beisbier, S. & Cahill, S. (2021). Occupational therapy interventions for children and youth ages 5 to 21 years. The American Journal of Occupational Therapy, 75(4), 7504390010p1-7504390010p6. https://doi.org/10.5014/ ajot.2021.754001
Breithart, D. (n.d.). What is pediatric occupational therapy?. My OT Spot. https://www.myotspot.com/pediatricoccupational-therapy/
Case-Smith, J., Frolek Clark, G. J., & Schlabach, T. L. (2013). Systematic review of interventions used in occupational therapy to promote motor performance for children ages birth-5 years. American Journal of Occupational Therapy, 67(4), 413-424. http://dx.doi.org/10.5014/ajot.2013.005959
Cerebral Palsy Alliance. (2016, September 12). Bimanual upper limb therapy. https://cerebralpalsy.org.au/ourresearch/about-cerebral-palsy/interventions-and-therapies/bimanual-upper-limb-therapy/
Cerebral Palsy Guidance. (2020, July 16). Assistive technology and adaptive equipment for children with cerebral palsy. https://www.cerebralpalsyguidance.com/cerebral-palsy/living/assistive-technology/
Chicago Occupational Therapy. (2021). 10 best benefits of pediatric occupational therapy. https:// chicagooccupationaltherapy.com/articles/10-best-benefits-of-occupational-therapy/
Cincinnati Children’s. (2021). Visual motor and visual perception. https://www.cincinnatichildrens.org/service/o/ ot-pt/visual-motor-perception
Dallman, A. R., Artis, J., Watson, L., & Wright, S. (2020). Systematic review of disparities and differences in the access and use of allied health services amongst children with autism spectrum disorders. Journal of Autism and Developmental Disorders, 51, 1316-1330. https://doi.org/10.1007/s10803-020-04608-y
Gouveia, D. (2018, April 5). The benefits and importance of pediatric occupational therapy. TLC Kids Therapy.
The Oak Leaf | Volume 3 - Issue 1 - Spring 2022 11
https://www.tlckidstherapynyc.com/2018/04/the-benefits-and-importance-of-pediatric-occupational-therapy/
Graham, F., Rodger, S., & Ziviani, J. (2009). Coaching parents to enable children’s participation: An approach for working with parents and their children. Australian Occupational Therapy Journal, 56(1), 16-23. https://pubmed. ncbi.nlm.nih.gov/20854485/
Greenwood, B. (n.d.). Geriatric care & occupational therapy. Chron. https://work.chron.com/geriatric-careoccupational-therapy-18951.html
Kid Sense. (2021). Behavior management. https://childdevelopment.com.au/areas-of-concern/behaviour/ behaviour-management/
Kray, L. (2017, May 30). Torticollis. Sensory Solutions. https://sensorysolutions.org/home/blog/torticollis/ Morin, A. (2020). Sensory integration therapy: What you need to know. Understood. https://www.understood.org/ articles/en/sensory-integration-therapy-what-you-need-to-know
Novak, I. & Honan, I. (2019). Effectiveness of paediatric occupational therapy for children with disabilities: A systematic review. Australian Occupational Therapy Journal, 1-16. https://www.researchgate.net/ publication/332325758_Effectiveness_of_paediatric_occupational_therapy_for_children_with_disabilities_A_ systematic_review
Pathways. (2020). What is a pediatric occupational therapist. https://pathways.org/what-is-a-pediatricoccupational-therapist/
Pawar, D. (2016, June 26). Behavior modification therapy. Occupational Therapy OT. https:// occupationaltherapyot.com/behavior-modification-therapy/
Pfeiffer, B., Clark, G. F., & Arbesman, M. (2018). Effectiveness of cognitive and occupation-based interventions for children with challenges in sensory processing and integration: A systematic review. American Journal of Occupational Therapy, 72, 7201190020p1-7201190020p9. https://doi.org/10.5014/ajot.2018.028233
Salokorpi, T., Rautio, T., Kajantie, E., & Von Wendt, L. (2002). Is early occupational therapy in extremely preterm infants of benefit in the long run?. Pediatric Rehabilitation, 5(2), 91-98. Retrieved September 19, 2021. https://search.ebscohost.com/login.aspx?direct=true&db=edsbl&AN=RN122040690&site=eds-live
Seattle Children’s. (2021). Occupational therapy. https://www.seattlechildrens.org/clinics/occupational-therapy/ Stanford Children’s Health. (2021). Outpatient occupational therapy services. https://www.stanfordchildrens.org/ en/service/occupational-therapy/outpatient-services
Top Occupational Therapy Schools. (2020). Occupational therapy for kids—Importance and benefits. https:// www.topoccupationaltherapyschool.com/occupational-therapy-kids-importance-benefits/
The Oak Leaf | Volume 3 - Issue 1 - Spring 2022 12
The Oak Leaf | Volume 3 - Issue 1 - Spring 2022 13
Parental Stress of Homeschool Parents Vs. NonHomeschool Parents
Alicia Lewis
Abstract
The purpose of this study was to explore the reasons why parents choose to homeschool their children versus sending them to public-school. This research was a survey comparing the parental stress levels of homeschool parents and public-school parents. It utilized the Parental Stress Scale designed by Berry & Jones (1995) to evaluate the stress levels of the parents responding to the survey with a total of 141 participants. Parents who homeschool their children showed a significantly lower parental stress score compared to the parents who sent their children to public-school. There was a second self-report question asking the parents to describe their reasons or motivations behind their choice in schooling. These results demonstrated that parents who homeschool have a higher perceived stress level compared to those who choose public schooling.
Keywords: homeschool, moral instruction, non-traditional, parental stress, perceived stress, public-school, special needs
Homeschooling long predates traditional public schooling. After the advent of traditional public-schooling, homeschooling become the exception rather than the norm. This shift in norms has also created a shift in definition. What people now think of as “homeschooling’ is quite different, and often misconceived, compared to the role homeschooling played in the past. Attending school was not always compulsory, but by 1918, every state had a law that dictated mandatory public-school attendance (Rakestraw & Rakestraw, 2019). At the time, there were laws enacted to mitigate child neglect and exploitation issues that had become a hinderance to schooling. Present day homeschooling evolved in reaction to the dissatisfaction of parents’ and educators with the state’s ways of teaching. John Holt and his friend Raymond Moore were among these reformers. They were both advocates for improving children’s education and wellbeing. After these reforms, homeschool is an approved option in all 50 states with varying degrees of
rules and regulations that were followed.
There were almost 100,000 homeschooled children in the mid 1980’s and that was a substantial increase from the 13,000 in 1973 (Ray, 2021). With an increase in families choosing to homeschool, conflicts arose. In 1983, two attorneys and homeschool parents, Mike Farris and Mike Smith founded the Homeschool Legal Defense Association or HSLDA. This group aids homeschooling families who run into issues with various governmental regulations and rules throughout the United States. Over time, homeschooling has grown to be an accepted and better understood form of education for families. According to the National Home Education Research Institute (NHERI) in the 2020/2021 school year, there were close to 3.7 million homeschooled children in the United States. This research shows that decisions to homeschool impacts lives of children and parents who choose to homeschool. It also makes an economic impact
The Oak Leaf | Volume 3 - Issue 1 - Spring 2022 14
on the lives of all taxpayers (Ray, 2021). According to the National Education Association or NEA, the public-school expenditure per student was $14,602 on average for the 2019/2020 school year (NEA, 2021). This $14,602 relates to the amount of taxes that people pay into school funding. The parents who choose to homeschool pay out of pocket an average of $600 per student and they do not rely on government funding (Ray, 2021). That is 3.7 million students not in publicschools, saving taxpayers an average of 54 billion dollars.
Homeschooling is a growing option in the United Sates and globally. There is an organization called Global Home Education Exchange Council. This organization has held three different global conferences in a sixyear time span covering Home Education (Cheng & Donnelly, 2019). Throughout the last 15-20 years, there has been a change in awareness of and support for homeschooling families. Through these changes in demographics there is a shift in the reason parents are choosing to homeschool. Research shows that from the 80’s to the early 2000’s a primary reason for choosing homeschooling was for religious influence (Cheng & Donnelly, 2019). Data collected and released in 2016 shows a shift away from these reasons for homeschooling (Cheng & Donnelly, 2019).
One topic that has little research support is the stress levels of parents who homeschool their children. Current research shows there are parallels between stress of professional educators and homeschool parents even though the settings are different (Myers, 2016). The present study will help to further understand the common stressors that parents experience, and help parents better handle the stressors of homeschooling life.
Review of Literature
Homeschooling is on the rise in the United States, and it is making an increase throughout the world. The National Education Association estimated that enrollment in public-schools would decrease by 2.4% for the 2019/2020 school year (NEA, 2021). Kunzman and Gaither (2020) report that most of the innovative research comes from outside of the United States; this is a huge change in the past 7 years. The growing awareness and drive to better understand the best ways to help children grow and learn is an important issue around the world. The present study seeks parents’ reasons for their choice in the type of schooling for their children, and to assess the level of stress the parents undergo. Much of the current research focuses on homeschool parents with children ranging from 5-13 years of age.
RQ: Do parents who homeschool have more parental stress than parents who choose other forms of schooling?
Hy: There will be a difference between the parental stress of parents who homeschool, and those who choose other schooling options.
Kunzman and Gaither (2020) found that parents’ reasoning for choosing homeschooling has stayed consistent over time. Parents continue to doubt the value of the school system but also doubt their own abilities to teach. Kunzman and Gaither (2020) showed that in the past most studies have found that parents’ choice to homeschool fell into two categories of either religious preferences or institutional/government rebellious types of reasoning. They also found that recent National Center of Education Statistics (NCES) show that 37% of the sampled parents state dissatisfaction with school environments and only 16% chose to homeschool based on the desire to provide religious instruction (Kunzman & Gaither, 2020). Green and Hoover-Dempsey (2007) showed that there was a strong belief in the parentfocused role in homeschooling children aged 5-13. They also found a strong belief that public schools lack the capacity to teach character development and to meet individual children’s needs (Green & HooverDempsey, 2007).
Other research has shown that a parents’ choice to homeschool their children has to do with the special needs of the child that the parent feels a public-school setting is unable to fulfill. Hurlbutt (2011) did a study of
The Oak Leaf | Volume 3 - Issue 1 - Spring 2022 15
9 homeschool families of children with autism spectrum disorder (ASD), with a total of 10 parents participating. The study found that the parents who homeschool their children with ASD feel that public schools have either been unwilling or unable to provide effective assistance for their ASD child and this feeling is a factor in choosing to homeschool. These families believe that the decision to homeschool is not a decision taken lightly and should be a family decision where they can create a more individualized and situational treatment to help their children with ASD. Ray’s (2021) analysis uses only peer-reviewed empirical studies to gain insight on the impacts of homeschooling on learning outcomes. The main reason participants in these studies chose to homeschool tends to be dissatisfaction with other schooling environments and standards, along with the desire to provide religious instruction. Redford et al. (2017) reported that 9 in 10 parents of homeschooled children reported concerns about the environment, like negative peer pressure, violence and safety, or poor moral and academic instruction, as an important reason for deciding to homeschool.
The demographic findings have also changed over time as homeschooling has progressed and grown as an alternative to other forms of schooling. Data gathered by Kunzman and Gaither (2020) examine the number of states that have research data showing homeschool enrollment charts over the years. According to the 2022 International Center for Home Education Research archive, in 2016, there were 30 out of the 50 states that showed data on how many homeschoolers there are registered in their respective states. Kunzman and Gaither (2020) also note that the cumulative research shows an increase in Hispanic and Black population of homeschoolers, though the majority are still Caucasian. An interesting stereotype that holds true across the demographic variables is that 78% of those responsible for the home education instruction is seen as the women’s role, according to the 2016 NHES (Kunzman & Gaither, 2020). Myers (2016) did research with Florida residents using 10 different identifiers for the demographics, and they surveyed 102 homeschool parents with children equivalent to ages of K- 6th grade.
Myers found that 67.6% were White, 21.6% were Hispanic, 5.9% were Black, and 4.9% were multiple ethnicities. One outcome of a systematic review done by Ray (2017) shows a variety of evidence showing the changes in demographics of homeschoolers. It states that of homeschooled children 62% were living in cities and suburban areas and 32% were of the minority group for ethnicity/race.
There has been less data gathered specifically examining the kinds of stress homeschool parents’ experience. Myers (2016) used the perceived stress scale (PSS) (Berry & Jones, 1995) to measure perceived stress levels in parents homeschooling children. Their theory that age, income, ethnicity, and level of education affect stress was not supported by their findings. Myers (2016) study defined stress as situations that are perceived to be beyond the parents means or ability and resources. They do suggest the possibility that stress levels are less related to teaching as a reaction to the interaction and characteristics of the child/children. Some parents decided to send their children into public-school after homeschooling for multiple years. These parents state their reason was wanting time for themselves and not having a break from the child was more stressful for them. The present study seeks to add to the literature regarding the perceived stress of parents with school aged children in the home.
The data gathered and analyzed tended to cover a small percentage of homeschool families and are not generalized to the larger population. There are still many informative results that help us better understand parents’ decision to homeschool and the perceived stress of parents who homeschool. Kunzmand and Gaither (2020) discuss how many states do not require registration for homeschooling. This creates difficulties getting a true sample of the demographics of homeschooling families.
Method
The following research was conducted as part of a required course assignment under the supervision of the instructor of record. The work done in this paper met
The Oak Leaf | Volume 3 - Issue 1 - Spring 2022 16
criteria for an exempt study and did not require a full IRB review.
Participants
Participant included 116 homeschool parents and 25 public-school parents with school children between the ages of 5 and 18. All participation in this study was voluntary. The survey was distributed via social media networks.
Materials
The current study utilized the following operational definitions.
Informed consent. Each participant signed an informed consent (See Appendix A). The informed consent included the purpose, procedure, potential risk, confidentiality of the study, and an explanation that this study is voluntary and can end at any time. The form also provided contact information for contacting the researcher of the study for any further questions or requests for responses.
Demographic survey. Each participant provided answers to gender, ethnicity, age, the number and age of children attending school in the home, and which form of schooling was utilized (homeschool, public, private, etc..). (See Appendix B)
Self-report on schooling choice. Each participant had the opportunity to answer a self-report style question about their reasons for choice in schooling (home, public, or private schooling). (See Appendix C)
Parental Stress Scale. Each participant filled out the questionnaire for the Parental Stress Scale. This test, designed by Berry and Jones (1995), is a reliable alternative to the larger Parental Stress Index (See Appendix D). This consisted of an 18 item self-report questionnaire using a 5-point scale of measurement. It measures the amount of stress of parents while also considering the normal positive and negatives of parenting.
Design and Procedures
First, each participant read and signed the informed consent. Second, each participant answered the demographic survey. Third, participants answered the self-report section covering the reason they chose their schooling option. Finally, each participant answered the Parental Stress Scale questionnaire. The design of this study was a quasi-experimental design.
Results
In this study, the subsequent research was analyzed to answer the following research question: Do parents who homeschool have more parental stress than parents who choose other forms of schooling? The study proposed the following hypothesis: There will be a difference between the parental stress of parents who homeschool, and those who choose other schooling options.
Descriptive Statistics
There were 155 participants who responded to the survey; the following cases were considered outliers in this study. In addition, I removed two private school responses due to an insufficient number of participants along with 11 additional participants due to multi-schooling homes. This action resulted in 141 participants’ data for the study. There was 100% female participation in the respondents with an average age of 39.7 (SD = 5.7) (See Figure 1). There were 82% homeschool parents and 18% Public-school parents for a total of 141 parents (See Figure 2). Of the 141 participants, 84% were Caucasian/White, 7% were Prefer not to say, 3% were African American/Black, 3% were Hispanic/ Latino, 1% were Asian, and 1% were Multiethnic (See Figure 3). The average number of school aged children in the home was 2.5 (SD = 1.3) with an age range of 5 years to 18 years. On average the parental stress was 35.1 (SD = 8.4) (See Figure 4).
The parental stress index of those who homeschool averaged 34.45 (SD = 8.08) and public school averaged 38.24 (SD = 9.12).
The Oak Leaf | Volume 3 - Issue 1 - Spring 2022 17
* Note. This table shows the age range of the parents who took the survey.
2 - Schooling Choice
* Note. This figure shows the percentages of the two different schooling choices surveyed.
The Oak Leaf | Volume 3 - Issue 1 - Spring 2022 18
0 2 4 6 8 10 12 14 16 18 2930313233343536373839403142434445464748495051525354555657 Number of Parents Parent Age
Figure 1 - Parent Age
82% 18% Homeschool Public-school
Figure
Figure 3 - Ethnicity





*Note. This figure shows the different percentages of ethnicity for the parents from the survey.
*Note. This figure shows the different percentages of ethnicity for the parents from the survey.
The Oak Leaf | Volume 3 - Issue 1 - Spring 2022 19
1% 3% 84% 3% 1% 7% Asian AfricanAmerican/Black Caucasion/White Hispanic/Latino Multiethnic Prefer not to say 0 10 20 30 40 50 60 1 5 9 13 17 21 25 29 33 37 41 45 49 53 57 61 65 69 73 77 81 85 89 93 97 101 105 109 113 Parental Stress Score Participants Public school HomeSchool
Figure
4 - Total Parental Stress
Analysis of Research Question
A t-test assuming equal variance was used to determine the difference between parental stress of homeschool and public-school parents. Homeschooling parents had a parental stress score (M = 34.45, SD = 8.09) and public-school parents showed a parental stress score (M = 38.24, SD = 9.12), t(139) = -2.08, p = .04.
Additional Analysis
Additional data between the parental stress results and number of children in the home analyzed using a t-test assuming equal variances.
These results show no significant difference in the number of children in the home and the level of stress on the Parental Stress Index scale.
Data analysis of the motivation for choice of schooling shows an imbalance with only 3 (Academic, Environmental, and Other) out of the 7 categories receiving data in the public-school option. For this study the category Other is used to categorize the less chosen options for a parent’s school choice. Homeschool had a 15% reasoning categorized as Other, compared to public-school at 48%. Homeschool showed a large contrast in the Environmental category at 11%, compared to public-school at 32%. Homeschool had an 11% categorized as Academic, compared to publicschool at 20%. At 25% nontraditional was the highest motivation for homeschooling parents (See Figure 5 below). It should be noted that many of the answers had multiple reasons for their schooling choice, but for the purpose of this study the answers were consolidated into one main reason.
The Oak Leaf | Volume 3 - Issue 1 - Spring 2022 20
Input 1-2 Children 3-6 Children Mean 34.443038 35.98387097 Variance 81.634534 55.09809625 Observations 79 62 Output Pooled Variance 69.989047 Hypothesized Mean Difference 0 df 139 t Stat -1.085526 P(T<=t) one-tail 0.1397838 t Critical one-tail 1.6558899 P(T<=t) two-tail 0.2795677 t Critical two-tail 1.9771777
Table 1 - t-Test: Two-Sample Assuming Equal Variances
*Note. This figure shows the percentage difference between the homeschool and public-school on reasons for choosing their type of schooling.
Discussion
In the current study, the parental stress was parents who homeschool and those who use public-school. The survey used the Parental Stress Index (Berry & Jones, 1995), and the results supported the hypothesis that there is a difference in parental stress between those who homeschool and those that choose another form of schooling. The results showed a significant difference between homeschool and public-school parental stress levels. There was not a significant difference in the parental stress and the number of children in the home. The data showed a difference in the parents’ reasons for their choice of schooling. There were only three categories of motivation that crossed over between homeschool and public-school: academic, environmental, and other. The largest of the three was Other and that was for public-school with 48% and only 15% for homeschool.




















There are few studies that cover the parental stress difference between homeschool and public-school. One study by Myers (2016) examined stress levels related to age, income, ethnicity, and level of education in
homeschool families. It did mention that parents who chose to send their kids to public-schools after multiple years of schooling did so because they wanted more time for themselves and needing a break from the stress of their children. In this study a reason for choosing public-school was “Honestly, I need a break from my children being home all day around me. I love them but I enjoy the quiet also. Plus, I really think they need the social interactions at school with peers,” stated by a parent from this survey.
Like the study by Kunzman and Gaither (2020), my study found that parents’ reasons for their schooling choices has remained consistent. Parents’ views of their own confidence and abilities to be effective in their teaching combined with their views of publicschools’ abilities to be effective in teaching their children has not changed much over time. Many parents choose to homeschool because of religious preference, environment insecurities, and flexibility or nontraditional approach to teaching. As Hurlbutt (2011) demonstrated, parents chose to homeschool for medical or special needs of the child, this study also found that
The Oak Leaf | Volume 3 - Issue 1 - Spring 2022 21 32% 20% 48% 21% 9% 11% 11% 25% 8% 15% Religious Moral Environmental Academic Non-traditional Special Needs Other
Figure 5 - Homeschool vs Public-school
to be a reason parents homeschool. They felt that the public-schools were ill-equipped to help their special needs child/children as effectively as the homeschool setting. One of the parent’s reasons for choosing publicschool was due to personal health problems; “personal health issue required I put them in public schools.” This study, like the Kunzman and Gaither (2020) study, found that most homeschooling families are Caucasian with an equal percentage of African American and Hispanic households.
Limitations
This study had an imbalance in the number of publicschool participants and homeschooling parents. There were 25 public-school responses and 116 homeschool. Also, all the participants were female with one male response getting removed due to being one of to few selected private school category. The written responses to the following question: “In a brief answer please express your reasons for choosing your form of schooling. What influenced your decision to choose to homeschool, public-school, private school, etc...?”, were interpreted and categorized manually by the researcher. The interpretation was done using a reference to the paper by Redford et al. (2017) and their categories of reasons for parents’ choice in homeschooling. The interpretation was adjusted to fit those parents who chose public-school, as described in my definition of terms section.
Future research
It would be beneficial to gather more equal data representatives in future research. Public schools could use the stress level of parents to help them implement new teaching strategies and improve the areas that are the biggest issue. It would be interesting to look at those families that do have multiple schooling forms and to better understand the motivations for these choices. Finding more support on these topics can further help parents who are struggling to make the best choice for their families in the future.
This study would also benefit from a more in-depth survey on the stress that parents deal with when either homeschooling, public-school, or any other forms of schooling. It is important to understand the stress that parents endure and to find solutions to help them cope with the stress in their lives. A more in-depth look into understanding the biggest stressors for a parent with school aged children would also be a good follow up to
this research. In learning the source of the stress, we can help find solutions and gain knowledge about different types of stress.
One thing this study did not explore was the outcomes of the different schooling choices. It would be beneficial to do a more in-depth study and see what differences there may be in the future education success of the children compared between types of schooling. With so much change since the Covid-19 pandemic forcing distance learning on the public-school setting, it would be beneficial to investigate the positive and negative effects of these types of learning. Future research could examine which learning settings might be more beneficial for implementation in the public-schools and how it can best help to successfully educate children.
The Oak Leaf | Volume 3 - Issue 1 - Spring 2022 22
References
Berry, JD, & Jones, W,H. (1995). The Parental Stress Scale: initial psychometric evidence. Journal of Social and Personal Relationships, 12, 463 – 472.
Cheng, A., & Donnelly, M. (2019). New frontiers in research and practice on homeschooling, Peabody Journal of Education, 94:3, 259-262, DOI: 10.1080/0161956X.2019.1617576
Green, C.L., & Hoover-Dempsey, K.V. (year). Why Do Parents Homeschool? A Systematic Examination of Parental Involvement. Education and Urban Society. 2007;39(2):264-285. doi:10.1177/0013124506294862 http:// focus.sagepub.com
HLSDA. (2019, September 18). History of hslda. HSLDA. Retrieved February 5, 2022, from https://hslda.org/ post/who-we-are
Hurlbutt KS. Experiences of Parents Who Homeschool Their Children with Autism Spectrum Disorders. Focus on Autism and Other Developmental Disabilities. 2011;26(4):239-249. doi:10.1177/1088357611421170 http://focus. sagepub.com
International Center for Home Education Research (2022) U.S. Enrollment Data https://icher.org/endata.html).
Kunzman, R., & Gaither, M. (2020). Homeschooling: An Updated Comprehensive Survey of the Research. Other Education: The Journal of Educational Alternatives, 9(1), 253–336. https://doi.org/ISSN 2049-2162
Myers, J. A. (2016). Parental Stress With Homeschooling K-6th Grade Children in a South Florida District (dissertation). ProQuest Dissertations Publishing, Ann Arbor, MI. Retrieved February 11, 2022, from https://www. proquest.com/docview/1802533324?pq-origsite=gscholar&fromopenview=true.
National Education Association. (2021). (rep.). Rankings of the States 2020 and Estimates of School Statistics 2021. Retrieved February 5, 2022, from https://www.nea.org/research-publications.
ND. (2020, November 23). National Home Education Research Institute (NHERI) - WELCOME! National Home Education Research Institute. Retrieved February 12, 2022, from https://www.nheri.org/
Rakestraw, J F. & Rakestraw, D A. (1990) Home Schooling: A Question of Quality, An Issue of Rights, The Educational Forum, 55:1, 67-79, DOI: 10.1080/00131729009339289
Ray, B. D. (2017) A systematic review of the empirical research on selected aspects of homeschooling as a school choice, Journal of School Choice, 11:4, 604-621, DOI: 10.1080/15582159.2017.1395638
Ray, B. D. (2021, September 24). Homeschooling: The research, scholarly articles, studies, facts, research. National Home Education Research Institute. Retrieved February 5, 2022, from https://www.nheri.org/research-facts-on-homeschooling/
Redford, J., Battle, D., and Bielick, S. (2017). Homeschooling in the United States: 2012 (NCES 2016-096.REV). National Center for Education Statistics, Institute of Education Sciences, U.S. Department of Education. Washington, DC.
The Oak Leaf | Volume 3 - Issue 1 - Spring 2022 23
Appendix A Informed Consent
Study Title: Perceived Stress of Homeschool Parents Vs. Non-Homeschool Parents
Researcher: Alicia Lewis
This study is part of a course requirement of my Psychology 4017 class at Louisiana State University of Alexandria. To participate in this research study, it is necessary that you give your informed consent. By signing this statement, you are indicating that you understand the nature of the research study and your role in that research and that you agree to participate in the research. Please consider the following points before signing:
· I understand that I am participating in psychology research.
· I understand this survey will take approximately 5-10 minutes.
· I understand that the purpose of this study is to better understand parental stress and gain insight into parents’ influencers for schooling choices.
· I understand that my identity will not be linked with my data, and that all information I provide will remain confidential.
· I understand that I may not expect to receive any benefits from participating in this study.
· I understand that my participation in this research project is voluntary, that my refusal to participate will involve no penalty or loss of benefits to which I am otherwise entitled, and that I may discontinue participation at any time without penalty or loss of benefits to which I am otherwise entitled
· I understand that I will be provided with an explanation of the research in which I participated and be given the name and contact information of an individual to contact if I have questions about the research. In addition, I understand that I may contact Alicia Lewis at alewis008@lsua.edu, if I have questions concerning my rights as a participant in psychological research.
By checking this box, I am stating that I am 18 years of age or older, that I understand the above information, and that I consent to participate in this study being conducted at Louisiana State University of Alexandria.
I have read the informed consent and agree to participate in this study
The Oak Leaf | Volume 3 - Issue 1 - Spring 2022 24
Appendix B
Demographics
Age: _____
Gender:
Female
Male
Other
Prefer not to say
Ethnicity
African American/Black
Asian
Caucasian/White
Hispanic/Latino
Middle Eastern
Multiethnic
Native American
Prefer not to disclose
Number of School Aged Children in the home?
Options 1-10
Select the age of each child? (Check all ages that apply)
Options 5-18
What form of schooling do you do?
Homeschool
Public school
Private school
Other
The Oak Leaf | Volume 3 - Issue 1 - Spring 2022 25
Appendix C
Self-report on schooling choice
In a brief answer please express your reasons for choosing your form of schooling. What influenced your decision to choose to homeschool, public school, private school, etc...?
Open area to fill in personal answer. Some examples of responses that the survey received.
Homeschooling
Ex 1: “The public school was not meeting my children’s educational needs. The students were not being taught grammar or writing skills because those skills weren’t as important for the standardized tests by which the school was graded. Through homeschool I can provide curriculum choices and extracurricular opportunities not available in public school. I can also educate them in a Christian environment at a lower financial cost than Christian private school, and I have a better relationship with my children because I am able to spend more time with them. They also have less exposure to the dangers in public school, such as being assaulted by other students.”
Ex 2: “Family flexibility and choice of curriculum.”
Public Schooling
Ex 1: “Access to broad subject range and experts on each subject to teach the children. I am not proficient in all subjects and want my children to learn from someone who has breadth and depth of knowledge.”
Ex 2: “Need Full time job for financial reasons, otherwise I would home-school.”
Ex 3: “Personal health issue required I put them in public schools.”
The Oak Leaf | Volume 3 - Issue 1 - Spring 2022 26
I am happy in my role as a parent.
Appendix D
Parental Stress Questionnaire (Parental Stress Scale) Sample
There is little or nothing I wouldn't do for my child(ren) if it was necessary.
Caring for my child(ren) sometimes takes more time and energy than I have to give.
I sometimes worry whether I am doing enough for my child(ren).
I feel close to my child(ren).
I enjoy spending time with my child(ren).
My child(ren) is an important source of affection for me.
Having child(ren) gives me a more certain and optimistic view for the future.
The major source of stress in my life is my child(ren).
The Oak Leaf | Volume 3 - Issue 1 - Spring 2022 27
Question Strongly Disagree Disagree Undecided Agree Strongly Agree
❏ 1 ❏ 2 ❏ 3 ❏ 4 ❏ 5
❏ 1 ❏ 2 ❏ 3 ❏ 4 ❏ 5
❏ 1 ❏ 2 ❏ 3 ❏ 4 ❏ 5
❏ 1 ❏ 2 ❏ 3 ❏ 4 ❏ 5
❏ 1 ❏ 2 ❏ 3 ❏ 4 ❏ 5
❏ 1 ❏ 2 ❏ 3 ❏ 4 ❏ 5
❏ 1 ❏ 2 ❏ 3 ❏ 4 ❏ 5
❏ 1 ❏ 2 ❏ 3 ❏ 4 ❏ 5
❏ 1 ❏ 2 ❏ 3 ❏ 4 ❏ 5
If You Must Touch a Turtle, Wash Your Hands
Jennifer Mathews
Abstract
Red-eared slider turtles are a freshwater invasive aquatic species in central Louisiana and many parts of the world. Many countries and states have a multitude of restrictions on red-eared slider turtles, including but not limited to unlawful wild release, have been done to gather information as to why they are successful at being invasive in diverse areas (CDC 2020). The CDC has linked outbreaks of Salmonella Oranienburg to pet turtles. Due to repeated outbreaks and risk, the Food and Drug Administration has made it unlawful to sell these turtles under a four-inch shell size and require disclosure of full risk and educational material to anyone purchasing these reptiles (CDC 2020). A small red-eared slider turtle was rescued by a student from a two-lane road after heavy rain in the spring of 2022. Seeking to gather data regarding the risks of the unnecessary handling of turtles, this study examined the microbial exposure associated with the turtle’s biome and immediate environment.
Keywords: Red-eared slider turtles; Salmonella Oranienburg
Introduction
The red-eared slider (Trachemys scripta elegans) is a subspecies of the pond slider (Trachemys scripta) in the Emydidae family. They are semi-aquatic in that they spend a significant amount of time outside the water in the sun. Red-eared slider turtles are an invasive species in central Louisiana and many parts of the world due to pet releases. It is unlawful to release them into the wild. Their natural region is the Southeastern United States and Northern Mexico. Studies have been done to gather information as to why they are successful in diverse environments. One probable reason is that they can go without food longer than many localized species of turtles (Zhao et al. 2013). Another reason is that their internal intestinal microbiome is rarely affected by water environments. A self-regulating microbiome allows the turtles to adjust easily to seasonal weather changes, varying food sources, and environments (Peng et al. 2020).
Turtle shells are known to harbor a unique microbiome but little is known about the makeup of those communities. Green algal growth on turtle shells has been reported since the 1800s, while less has been known about prokaryotic organisms. Molecular techniques now allow a greater understanding of both the prokaryotic and eukaryotic microbial communities on the shells of common freshwater turtle species including the redeared slider. Understanding the common microbial communities of these turtles is a potential indicator of the overall health of their environment (Parks et al. 2020).
The CDC has linked outbreaks of Salmonella Oranienburg to pet turtles. From May to October 2019, of the twenty-two people interviewed in this outbreak, sixteen reported contact with a pet turtle. Eight of these individuals identified the species of the turtle as redeared sliders. These infected people reported either buying the turtles themselves as pets from pet stores
The Oak Leaf | Volume 3 - Issue 1 - Spring 2022 28
or the turtles given to them by others (CDC 2019). In 2020, a Salmonella typhimurium outbreak occurred due to the handling of red-eared slider turtles. Thirty-five people from nine states were affected (CDC 2020). Due to repeated outbreaks and risk, the CDC has made it unlawful to sell these turtles under a four-inch shell size and required disclosure of the full risk and educational material given to anyone purchasing these reptiles. The four-inch shell size was chosen because small children are more likely to handle small turtles. It is highly advised against small children, immunocompromised individuals, and elderly persons having reptiles in the home due to associated risks of infection (CDC 2021).
Chiacchio et al. (2014) studied enterobacterial colonization in captive red-eared sliders. They used a sample pool of thirty-nine adult red-eared sliders that had been in captivity for seven years. They did not find Salmonella spp. but they did find Kluyvera ascorbate (38/39), Leclercia adecarboxlata (37/39), Raoultella planticola (30/39), Citrobacter freundii (20/39), Proteus spp. (15/39), and Escherichia coli (5/39).
Parks et al. (2020) surveyed and studied the microbial composition on the shells of red-eared sliders in their environments from Oklahoma to southeast Iowa. The authors wanted to determine if the presence of microbial communities on T. scripta shells would reflect the overall health of both the environment and the turtle. Using advanced molecular sequencing techniques, they were able to recover human pathogenic bacteria from at least ten different genera. Most of the isolated organisms were found on both the shell and in the environment. However, the turtle shells additionally harbored two additional genera, Enterococcus (Enterococcaceae) and Francisella (Francisellaceae). These findings suggest that while the shells could carry pathogens from the environment, there was not enough evidence to correlate shell microbial communities with pathogenic bacteria outbreaks in aquatic environments. However, the authors concluded that their data suggested that freshwater turtle shells could act as a reservoir for the accumulation of pathogenic bacteria. The authors suggested that these turtles may transmit regional
microbial communities during habitat selection, nestseeking, and mate-seeking. The authors also found that the turtles shared microbes with other animals common in their environments, such as the river cooter (Pseudemys concinna, a species of freshwater turtle in the family Emydidae). However, their microbiome was not dependent upon the environment (Parks et al. 2020).
Selvarajah and Khairani-Bejo (2019) evaluated sixty red-eared slider turtles from fifteen pet shops. Four turtles were selected randomly from each shop, and 10 ml of aquarium water was pipetted out of their tanks for evaluation. A total of thirty-six bacteria were isolated. The most common organism from both cloacal swabs and aquarium water was Aeromonas spp. Significantly, in percentage, Klebsiella spp. (50%), Escherichia coli (33.3%), and Yersinia spp. (16.7%) were present in substantial amounts overall. Six Salmonella serotypes were also detected and identified. This information reinforces the importance of risk education and responsible ownership of these creatures as pets.
Objective
The objective of these experiments was to humanely collect samples to provide informative data regarding the risks of the unnecessary handling of turtles by identification of the microbial exposure associated with their biome and immediate environment.
Materials and Methods
A small red-eared slider turtle was rescued by a Microbiology student from a two-lane road after heavy rain in the spring of 2022 from the central region of the State of Louisiana. The student was not wearing appropriate protective equipment when handling the turtle, such as gloves, and proper hand washing measures were also not being practiced. The turtle was being passed amongst other students whereas the same negligence was observed including the touching of multiple surfaces which inspired the collective research behind this research paper.
The turtle was approximately four inches in shell size and appeared healthy and active. The turtle was placed
The Oak Leaf | Volume 3 - Issue 1 - Spring 2022 29
in a clean habitat from the animal lab and provided water from the tap in the animal lab, and a medium limb with intact bark was partially submerged to provide support to get air. The turtle was fed Fluker’s Buffet Blend pellets daily. The water was changed once over the course of one week before the turtle was released back to its original environment. The experiments were conducted as part of the regular lab activities in BIOL 2051, General Microbiology.
Samples were taken of the tank water over an eightday period after rescue (once before the initial tank water change, Sample one, and once after the tank water change, Sample two). One ml of tank water was pipetted with each sample and cultured on a nutrient agar dish. A tail swab was conducted on the turtle’s skin and plated on a nutrient agar to be cultured.
Sample one, (Fig. A; A-2), and Sample two, (Fig. B), of the turtle’s water cultured an uncountable number of diverse types of colonies that varied in shape, variety, and color. With a limited time, only a few colonies were
isolated and subjected to differential microbial testing to determine the identification of the unknown organisms.

A dark yellow colony, (Fig 1-2), from Water Sample 1 (Fig A; A-2) and an off-white abnormally shaped colony (Plate 2) from also from Water Sample 1 were isolated. A non-feather-like off-white colony, (Fig. 6-7), isolated from the tail swab was collected and cultured to Plate 3. Differential testing was conducted on the feather-like colony found in the tail swab sample. This feather-like colony, (Fig. 16 –18), once isolated onto agar, possessed a unique morphology and thus was soley selected for the following biochemical testing: Methyl red mixed acid fermentation– Results: negative; Voges Proskauer presence of acetoin– Results: positive; Presence of catalase enzyme– Results: positive; Presence of nitrate gases– Results: positive; Motility– Results: strongly positive; Fluid Thioglycolate- Results: Facultative anaerobe. A Red Giant colony, (initially presented and then again in Fig. 10-11), found in Water Sample 1 was isolated on a streak plate. From three samples, four isolated plates total were produced.

The Oak Leaf | Volume 3 - Issue 1 - Spring 2022 30
Red Giant colony discovered in Water Sample 1 prior to be transfered to streak plate. (Emphasized - See Fig. 10-11)
Figure A. Water Sample 1 cultured to agar revealing large quantities of various bacterial growth. (General; Front)
The tail swab sample visually seemed to grow two morphologies of bacteria, a feathery, rhizoid-type off-white colony, (Fig. 16), and another amorphous colony that was also off-white in appearance, (Fig.67). The feathery rhizoid-type colony was cultured on a blood agar plate, (Fig. 14-15), and the off-white colony of focus from the Water Sample colony isolated to Plate 2 from Figure 4 was isolated via a streak plate. There was a visually red colony growing on this initial plate, but since we had found one was also found on the control plate, it was disregarded.



Results
The following are the samples cultured, the tests conducted, and the images of those tests.


The Oak Leaf | Volume 3 - Issue 1 - Spring 2022 31
Figure A-2. Water Sample 1 cultured to agar revealing large quantities of various bacterial growth. (General; Back)
Figure B. Water Sample 2 cultured to agar, again revealing stunning amounts of bacterial growth. (General; Front)
Fig 1. Isolated from Water Sample 1 to Streak Plate P1: Dark yellow colony. Revealed:Gram-negative cocci. (Front View)
Fig 2. Isolated from Water Sample 1 to Streak Plate P1: Dark yellow colony. Revealed:Gramnegative cocci. (Back View)
Figure 3. Tank Water Colony from Figure 1 and 2; Gram Stain; Revealing: Gram-negative cocci
produced a NonFeather like Colony when cultured to agar and isolated to a Streak Plate (P3); Revealed: Gram-negative, small cocci, amorphous. (Back)



isolated to a Streak Plate (P3); Revealed: Gram-negative, small cocci, amorphous. (Front)

The Oak Leaf | Volume 3 - Issue 1 - Spring 2022 32
Figure 4. Isolated off-white colony from Tank Water Plate 2 (P2) onto Streak Plate; Revealed: Gram-positive, tiny diplobacilli, beta-hemolytic, possibly Corynebacterium.
Figure 5. Microscopic Imagery of Figure 4 Gram Stain; Revealed: Gram-positive, tiny diplobacilli, beta-hemolytic, possibly Corynebacterium. (Secondary Image)
Figure 6. Sample collected as a Tail Swab
Figure 7. Sample collected as a Tail Swab produced a NonFeather like Colony when cultured to agar and




The Oak Leaf | Volume 3 - Issue 1 - Spring 2022 33
Figure 8. Sample collected as a Tail Swab produced a Non-Feather like Colony when cultured to agar and isolated to a Streak Plate (P3); Picture represents Gram Stain Results: Gramnegative, small cocci, amorphous.
Figure 10. Red Giant Colony isolated from Water Sample 1 onto a Streak Plate. Revealed: Gramnegative, rod-shaped, hemolytic; possibly Serratia (Back)
Figure 9. Sample collected as a Tail Swab produced a Non-Feather like Colony when cultured to agar and isolated to a Streak Plate (P3); Picture represents Gram Stain Results: Gram-negative, small cocci, amorphous. (Secondary Image)
Figure 11. Red Giant Colony isolated from Water Sample 1 onto a Streak Plate. Revealed: Gramnegative, rod-shaped, hemolytic; possibly Serratia (Front)




The Oak Leaf | Volume 3 - Issue 1 - Spring 2022 34
Figure 12. Red Giant Colony isolated from Water Sample 1 onto a Streak Plate. Image reveals Gram Stain Results: Gram-negative, rod-shaped, hemolytic; possibly Serratia.
Figure 13. Red Giant Colony isolated from Water Sample 1 onto a Streak Plate. Image reveals Gram Stain Results: Gram-negative, rodshaped, hemolytic; possibly Serratia. (Secondary Image)
Figure 14. Sheep’s Blood Agar dish was split to test both the Red Giant Colony from Fig. 10-11 and the Off-White Water Colony from Fig. 4; Revealed: Both are Hemolytic (Back)
Figure 15. Sheep’s Blood Agar dish was split to test both the Red Giant Colony (Left) from Fig. 10-11 and the Off-White Water Colony (Right) from Fig. 4; Revealed: Both are Hemolytic (Front)
Due to the quantity of bacteria cultured from our samples and with a limited time, only a few colonies were isolated and subjected to differential microbial testing to determine the identification of the unknown organisms. The tail swab feather colony, (Fig.16-18.), was isolated and cultured on nutrient agar. It was found to be particularly interesting due to it’s unique morphology and thus was soley selected for biochemical testing. The following is the results of those findings.

• Methyl red mixed acid fermentation–negative

• Voges Proskauer presence of acetoin–positive
• Presence of catalase enzyme–positive
• Presence of nitrate gases–positive
• Motility–strongly positive
• Fluid Thioglycolate-Facultative anaerobe

The Oak Leaf | Volume 3 - Issue 1 - Spring 2022 35
Figure 16. Tail Swab Sample isolated from Plate 3 and cultured on agar showing an off-white feather- like colony. Biochemical testing was done on this colony; Results revealed below.
Figure 17. Tail Swab feather-like colony, isolated from Plate 3; Gram stain; Revealed: Gram-negative, extremely small cocci, amorphous. (First Image)
Figure 18. Tail Swab feather-like colony, isolated from Plate 3; Gram stain; Revealed: Gram-negative, extremely small cocci, amorphous. (Secondary Image)
Discussion
Owning a turtle as a pet is a great commitment not only in maintaining health standards for the pet outside of its natural environment but also in responsibly maintaining strict handling standards of the pet. Turtles, specifically red-eared sliders, can live 30+ years and with so many in the population, it may be difficult to find a donation center willing to take a pet without a significant wait if the situation changes in being able to care for the reptile long term (Surrendering a Turtle 2022).
Although we were not able to sequence our findings to be able to confidently identify the bacteria cultured from our samples, the sheer number of bacteria that we were able to culture from the original sample plates brings a heightened awareness of the necessary caution required when handling these reptiles and exposure to their environments. We were able to confirm that five out of the six bacteria that we isolated were, in fact, gram-negative bacteria which are widely known to be more resistant than their gram positive counterparts and thus commonly pose a greater threat when it comes to treatment of infection. We also suspect that the gram positive bacteria isolated and cultured from the Water Sample to be Corynebacterium which is known as a causative pathogen in immunocompromised humans and also the cause of pneumonia and lower respiratory tract illness. The Red Giant colony, also isolated from a Water Sample, is strongly suspected to be Serratia. Serratia is well recognized as a human pathogen ranging in it’s various forms from significant to opportunist. It is associated with hospital acquired infections and a spectrum of various clinically significant illnesses.
Our data collected confirms the information provided from prior studies on the red-eared slider species and their ability to house an overwhelming quantity of bacteria on their bodies, shells, and in their environment. It is important to be educated on the risk factors of having such a reptile in the home and to be able to know the symptoms associated with infection due to the pathogenic nature of bacterial exposure.
It is important to note that it is a myth that bacteria can be removed from turtles (CDC 2007). People
searching for a method to do this or how to obtain turtles without Salmonella is something I came across many times in my research and on search engines which is frightening. It is part of their microbiome. Cleaning turtles or attempting to do so by any means, even those guaranteed on the internet, will only damage the turtle’s health, and may even accelerate its microbial growth in an effort to heal itself. I encourage you to be proactive in educating yourself on the updated resources provided to the public from the Center of Disease Control and Prevention’s section on ‘Reptiles and Amphibians: Healthy Pets, Healthy People’ regarding care instructions of your pet, Federal Law mandates, Salmonella risks, symptoms of suspected Salmonella infection, habitat care, outbreak postings, myth busters, and much more at https://www. cdc.gov/healthypets/pets/reptiles.html.
The Oak Leaf | Volume 3 - Issue 1 - Spring 2022 36
Literature cited
CDC. 2007. Turtle-associated salmonellosis in humans—United States, 2006—2007. Morbidity and Mortality Weekly Report. [accessed November 6, 2022] https://www.cdc.gov/mmwr/preview/mmwrhtml/mm5626a1.htm
CDC. 2019. CDC: Outbreak of salmonella infections linked to pet turtles. (2020, January 9). [accessed 2022 May 10] https://www.cdc.gov/salmonella/oranienburg-10-19/index.html
CDC. 2020. The outbreak of salmonella infections linked to small pet turtles. [accessed 2022 May 10]. https:// www.cdc.gov/salmonella/typhimurium-1-20/index.html
CDC. 2021. CDC: Salmonella outbreaks linked to small turtles. Centers for Disease Control and Prevention. [accessed 2022 May 10] https://www.cdc.gov/salmonella/typhimurium-02-21/index.html
Chiacchio RGD, Penido GN, de Souza CAI, Prioste FES, Prado MS, Knöbl T, Menão MC, Matushima ER. 2014. Enterobacterial colonization in colonization in captive red-eared sliders (Trachemys scripta elegans). J Zoo Wildlife Med. 45(4): 919–921. http://www.jstor.org/stable/24551345
Parks M, Kedy C, Skalla C. 2020. Consistent patterns in 16S and 18S microbial diversity from the shells of the common and widespread red-eared slider turtle (Trachemys scripta). PLoS ONE 15(12): e0244489. https://doi. org/10.1371/journal.pone.0244489
Peng Q, Chen Y, Ding L, Zhao Z, Yan P, Storey KB, Shi H., Hong, M. 2020. Early-life intestinal microbiome in Trachemys scripta elegans was analyzed using 16S rRNA sequencing. Peer J. 8: e8501. https://doi.org/10.7717/ peerj.8501
Selvarajah GT, Khairani-Bejo S. 2019. Identification of Salmonella and other pathogenic bacteria in pet red-eared sliders, Trachemys scripta elegans, from pet shops in the Klang Valley. J Vet Malaysia. 31(2): 23-27.
Surrendering a Turtle. 2022. Mid-Atlantic Turtle & Tortoise Society. [accessed October 31, 2022] http://www. matts-turtles.org/surrender-a-turtle.html
Zhao LH, Li J, Wei CJ, Wang JC, Hone ML, Shi HT. 2013. Comparisons on the competitive ability for food between Trachemys scripta elegans and Mauremys sinensis. Sichuan J Zoology. 32:873–878.
The Oak Leaf | Volume 3 - Issue 1 - Spring 2022 37
(Sondheim & Lapine 74). These words are spoken when the magical properties of Into the Woods’ titular woods are realized. The journey through the woods symbolizes change, but these woods have more than just a symbolic impact on character development. As the characters of Into the Woods change in these woods, so do their words. With music and lyrics by Stephen Sondheim and a book by James Lapine, Into the Woods is the musical fable of a childless baker and his wife on a quest through the woods to break a family curse, their interactions with several fairy tale characters, and the consequences of wishes (Sondheim 57). Sondheim infuses his lyrics with linguistic concepts such as pragmatics, code switching, social meaning, and registers of speech to turn the woods into a metaphor for the process of language acquisition. Sondheim plays with phonological, morphological, and syntactical traits to give his characters defined sociolinguistic characteristics, which evolve as they intermingle and are influenced by the strange environment of the woods, demonstrating the productivity and the force of language.
Sondheim and his collaborator James Lapine weave together famous fairy tales to create a contemporary fable based on the complex metaphor of life as journey that pervades folktale and fairy tales across many cultures. In these tales, “a purposeful life becomes a journey in which life goals are destinations... difficulties in life are impediments to travel… and material resources and talents are provisions” (Herrero Ruiz 144). The characters in the musical set out on a journey that takes them into the woods, the “all-purpose symbol of the unconscious, the womb, the past, the dark place where we face our trials and emerge wiser or
destroyed” (Sondheim 58). Accessing the cross-cultural pervasiveness of fairy tales, Sondheim and Lapine center their fable around contemporary characters in which the audience can recognize themselves (Herrero Ruiz 138; Sondheim 58).
Just as conceptual metaphors in fairy tales transmit commonplace knowledge to the reader, Sondheim and Lapine are using the structure of the fable and the poetic function of musical theatre to transmit ideas about meaning to the audience. Deirdre Wilson, British linguist, states that “an author may be simultaneously performing acts of communication on two different levels: a lower-level act of describing a fictional world, and a higher-level act of showing this world to the reader as an example of what is possible, or conceivable” (qtd. in Bennett 150). Sondheim’s lyrics operate on multiple levels of referential meaning, as fictional utterances within the world of the play and as utterances outside the world of the play – to the audience (Bennett 149). Dramatizing this imaginary fantasy world as a musical expands the expressiveness of language, turning the lyrics into “an unmediated, authentic, primitive language that could “say” all that words could not” (qtd. in Symonds 247). For instance, Cinderella and Rapunzel use the long open vowel sound /a/, making exclamatory sighs which convey a wealth of inward emotion, written lyrically as “Ahhh…” or “Ah Ah-ah ah ah-ah ah.” Language is “at the limit of its resources, at a barrier where conventional words are powerless to express what goes on in the hearts of the characters” (Cor 37). Cinderella’s Prince alludes to this later in “Agony,” being moved “beyond power of speech” (Sondheim & Lapine 63).
As the characters journey through the woods, their interactions result in noticeable linguistic consequences;
The Oak Leaf | Volume 3 - Issue 1 - Spring 2022 38
“There’s something about the woods”
“Careful the Things You Say”: Meaning, Language, Woods, and Words in Sondheim’s Into the Woods
Kane Prestenback
“You’ve changed… you’re different in the woods,” the Baker’s Wife says (Sondheim & Lapine 73). Included among these linguistic changes, characters assign new referential meanings to words, new words enter their lexicon, or the phonetic characteristics of their utterances shift and expand. For instance, in the lyrics of “Maybe They’re Magic,” after establishing the gradable semantic properties – the range of comparative or superlative words related to the elements of meaning that make up the lexical entry of a word in the speaker’s mind – found in “rights and wrongs and in-betweens,” the Baker’s Wife proclaims that “if the end is right / it justifies / the beans” (Rowe & Levine 153, 401; Sondheim & Lapine 37-38). The Baker’s Wife has created an anomalous utterance that presupposes her meaning of the commonly understood phrase justifies the means. Her time in the woods has allowed her to break idiomatic convention by using a minimal pair –two words “that differ in meaning, contain the same number of sound segments, and display only one phonetic difference” at the same place in the word – to expand the semantic properties of the words (Rowe & Levine 399). This emboldens the Baker to reconsider the referential meaning of cloak just moments later in “Baker’s Reprise.” He states, “What’s a cloak? / It’s a joke… and a cloak is what you make it” as he resolves to steal the cloak from Little Red Ridinghood (Sondheim & Lapine 41).
Little Red Ridinghood and the Wolf’s discourse in the lyrics of “Hello, Little Girl” explores the mystifying influence the woods have on lexical semantics – the meaning of words (Rowe and Levine 398). The Wolf confides his gourmandizing intentions to the audience, describing Little Red as flesh, plump, tender, fresh, lush, and delicious. Intending to describe her in gastronomical terms, these words are also loaded with sexual connotations. As The Wolf crosses referents, his speech patterns take on an undulating, circular rhythm that hints at the sensuality of his language while indicating a need to restrain his carnal appetite. The stress pattern on the phonemes in “Think of that scrumptious carnality / twice in one…” fall on the first phoneme in a three-syllable pattern, generating
a hypnotic rhythm which breaks free on “… day!” (Sondheim & Lapine 30). Unable to fully express meaning with his befuddled linguistic competence, his speech concludes that “There’s no possible way / to describe what you feel.” He is trying to break out of the three-syllable pattern, like a broken record trying to stop skipping. He concludes, saying “when you’re talking to your meal,” finally able to accurately convey his referential meaning to himself and the audience. In addition to this expansion of semantic complexity, the Wolf’s speech affects Little Red’s lexical characteristics and the frequency of certain phonemes. The Wolf speaks to Little Red with vowel sounds such as / /, / / and / /, all back vowels, in words such as rush, slow, flowers, and hours. The sounds are sensual in nature, while onomatopoetically mimicking a wolf’s call. In contrast, Little Red uses the short clipped front vowel / / in said, ahead, and misled with a tick-tocking rhythm. The wolf charms Little Red by copying her front vowel sounds, using the front /i/ sound in sweetly and fleetly. When mimicry doesn’t convince Little Red, the Wolf switches to the mocking nasal consonants of exploring, boring, and ignoring. These sounds surprise Little Red into considering the Wolf’s proposition. The next time Little Red speaks, back vowels in suppose, might like, and bouquet alternate with her front vowel sounds in stray and delay. She has agreed to a small delay, stopping to pick flowers for Granny.
The minor differences shown in the two Prince’s characterizations elicit sociolinguistic analysis – the study of how language and social factors are related – that reveals them to be basically the same man and provides commentary on the genericness of the fairy tale prince (Rowe & Levine 402). Their similarities are highlighted when they are seen together for the first time in “First Midnight.” They utter the same idiomatic phrase, “The harder to get, the better to have…” as if they share a lexicon (Sondheim & Lapine 52). Surprised by their similarity, Cinderella’s Prince confirms their shared identity by asking, “Agreed?”, to which Rapunzel’s Prince responds using the same word, going no further into their shared lexicon, only changing the sentence type from interrogative to declarative. The effect that

The Oak Leaf | Volume 3 - Issue 1 - Spring 2022 39
the two Princes’ elite social class has on their use of language is explored in the lyrics of “Agony.” They share the same level of formality in phrase structure. For instance, Cinderella’s Prince says, “If I should lose her / how shall I regain…” and Rapunzel’s Prince says, “You know nothing of madness” (Sondheim & Lapine 63, 65). Their lyrics often go out of the way to rearrange the syntax to put emphasis on themselves through movement transformation and topicalization, such as “the heart she has won from me,” implying that they prefer to focus on themselves. Passive voice is used to grammatically rearrange the constituents to position themselves as the subject of sentences. They conclude the song, singing together, “I must have her to wife,” employing a rarely used verb form of wife (Sondheim & Lapine 65; “Wife,” def. 3). Their particularly formal use of language sets them apart from the other characters, making them appear buffoonish and distantly removed from the realities of this world. Combined with the sameness evidenced by their linguistic traits, their pompous self-absorption and archaic verbiage lampoons the sociolinguistic traditions of the fairy tale prince.
Cinderella is particularly concerned with defining the traits of her Prince, though since she is a peasant, she does not have a wide lexicon; applying the concept of linguistic relativity – that “people of different cultures think and behave differently because the languages they speak influence them to do so” – to her worldview suggests that her inability to fully articulate what she wants might structure her initial decisions in the woods (Rowe & Levine 223). When she first appears in “Act I Opening, Part 3,” she is repeating a mantra that indicates a synonymous, simple relationship with her words, “So be Nice, Cinderella / Good, Cinderella /Nice good good nice…” (Sondheim & Lapine 11). Later, in “A Very Nice Prince,” she continues this pattern of unmarked word choices, describing the Prince and the ball as nice, adding only the adjective very as a descriptor. Though the Baker’s Wife presses for more information, she says “I don’t meet a wide range / and it’s all very strange” (Sondheim & Lapine 50). She doesn’t have words to describe the ball or the behavior of the prince. Since
the Baker’s Wife and Cinderella both come from the same sociological class, they are unable to expand each other’s meaning. Later, after repeated adventures at the ball throughout her journey in the woods, she becomes quite descriptive in “On the Steps of the Palace.” Nice becomes smart, saying “He’s a very smart prince,” and she goes on to describe many more qualities of the Prince and her experience at the ball (Sondheim & Lapine 86). Announcing that “you’ve learned something, too, / something you never knew,” she has acquired new meaning during her time on the steps of the palace and expanded her understanding of the semantic properties of princeness (Sondheim & Lapine 87).
During “Giants in the Sky,” Jack marvels at “know[ing] things now that [he] never knew before” while illustrating the anomalous and contradictory possibilities of a word’s semantic properties (Sondheim & Lapine 57). Jack recounts his experience with the giants, at first explicating the semantic properties with adjectives such as big, tall, and terrible. By the end of his tale, he includes adjectives that would have been considered anomalous prior to his experience, now stating that “there are big tall terrible awesome scary wonderful giants in the sky” (57). The sentences could be synonymous now that the semantic properties of giantness have been expanded. And the order of the words is important, considering the scope of adjectives regarding structural semantics. By placing wonderful immediately before the noun, the audience can infer that all giants contain something wonderful about them. From the audience’s perspective, knowing these things may also contain a sexual connotation. Sondheim surprises the audience when he reveals that the giant that Jack discusses is a lady giant, and Jack goes on to mention the nurture he receives from her which begins to awaken him to those things he “never knew before.” Recapping her experience with the wolf, Little Red demonstrates her expanded lexicon and echoes Jack’s acquisition of new meaning by saying, “And I know things now, / many valuable things, / that I hadn’t known before” in “I Know Things Now” (Sondheim & Lapine 44). Little Red has also experienced an awakening of sorts through her exposure to the Wolf
The Oak Leaf | Volume 3 - Issue 1 - Spring 2022 40
in “Hello, Little Girl.” As previously mentioned, the Wolf’s words contain affective meaning that conveys sensuality and carnal desire. But Little Red Ridinghood has not learned to associate those words with this affective meaning, understanding them simply for their more referential meanings. After the near-death encounter with the Wolf, Little Red alludes to acquiring a deeper understanding in “I Know Things Now.” She uses the words excited and scared interchangeably, even remarking on their interchangeability, saying “he made me feel excited, / well, excited and scared” and “I really got scared, / well, excited and scared” (44). She realizes that “though scary is exciting / nice is different than good” (45). In the woods, these characters are questioning their understanding of the meanings of things, demonstrating the productive nature of language by producing and comprehending utterances they “hadn’t known before.” While the characters expand their linguistic competence, the linguistic ambiguity allows the audience to infer alternate connotations in the words.
But there is a limit to how far the characters can change, as dictated by the hypothesis of linguistic determinism and seen in the interaction between Cinderella’s Prince and the Baker’s Wife. As defined in the Stanford Encyclopedia of Philosophy Supplement to Relativism, the strong version of linguistic relativity suggests that “our thought is ‘at the mercy’ of our language … we are ‘compelled’ to read certain features into the world” (qtd. in Rowe & Levine 225). In “Any Moment,” the cultural differences between the two are stated directly by the Prince in his seduction of her. He states, “Life is often so unpleasant, / you must know that as a peasant” trying to convince her to indulge in the moment, when “right and wrong don’t matter” (Sondheim & Lapine 148) As if to demonstrate the polysemous nature of a moment, that it could be both luxuriated in and cut short, almost immediately the Prince has to leave, explaining that “this was just a moment in the woods” (150). He leaves stating “every moment is of moment / when you’re in the woods,” where moment refers to both a very brief period of time and noted importance. The Prince’s use of the formal definition further demonstrates the
cultural differences between the two. Their language is inconsistent, they do not match, which the Baker’s Wife acknowledges by repeating that she is “in the wrong story” (147). She blames this dalliance on the woods:
Must it all be either less or more
Either plain or grand?
Is it always “or”?
Is it never “and”?
That’s what woods are for:
For those moments in the woods... (Sondheim & Lapine 152)
The Baker’s Wife plays with the idea of antonyms as complementary pairs to illustrate how the woods are a space in which things change; it has the power to alter a person’s point of view and reveal deeper meaning, much like new words have the power to alter and add meaning to the social world of the speaker. The magical power contained in the woods is synonymous with the transformative power of language. She chooses to return to her regular life with the “or meaning more than it did before,” acknowledging the danger involved in such learning (153).
This danger is explicitly cautioned in the Witch’s stanza of “Act II Finale.” “Careful the things you say, / children will listen,” she says to the audience (Sondheim & Lapine 185). Rowe and Levine point out that in many cultures, warning children to “watch what they say” demonstrates “awareness of the power of the spoken word to change the social environment” (Rowe & Levine 168). Sondheim is instructing the audience to choose their words carefully. The lyrics allude to the process of language acquisition and indicate an understanding of the theory of linguistic relativity, that people think and behave based on the influence of the language they speak (Rowe & Levine 223). “Children will see / and learn,” the witch continues (Sondheim & Lapine 185). The lexicon of a culture reinforces what that culture knows about itself. The witch is also reinforcing these pragmatic concepts of social meaning, affective meaning, and maxims of speech. Words must be carefully selected, as they can carry many meanings depending on many contextual situations. The chorus adds to the Witch’s speech act, adding that the audience
The Oak Leaf | Volume 3 - Issue 1 - Spring 2022 41
should consider the power of language beyond its impact on children, expanding “past what you can see” (186).
Sondheim broadens the transformative power of the woods to include the audience’s ability to grasp the transformative power of language. Laurence Cor, author of “Phonic Aspects of Language in the Theater,” suggests that “on the stage, the symbols… are psychological stimuli. Language, no longer simply a vehicle of ideas, becomes a sensory phenomenon… and may even recreate the synaesthetic [sic] values of words that children tend to appreciate” (Cor 39). The audience is engaged in a discourse with the chorus, challenging them to be more aware of their use of language: “Though it’s deep, / though it’s dark /… You have to listen / you can’t just act, / you have to think” (Sondheim & Lapine 186). Because Sondheim has so discreetly instructed the audience to listen carefully and look for the deeper meaning, the audience can see beyond the referential meaning of the characters’ words and start to expand their understanding for implied shades of meaning.
The poetic function is a constant presence in theatrical utterances, though some are more hidden than others (Jasna 156). The giants that Jack spoke of in “Giants in the Sky” take on deeper meaning, as the audience considers the many giants that they may come up against in life. The fact that Jack tells his story in secondperson perspective, summarizing that “you think of all of the things you’ve seen… and you’re back again only different than before / after the sky,” demands that the audience reconsider the metaphorical giants which they may encounter on their personal journeys (Sondheim & Lapine 57). This reconnects to the conceptual metaphors found in fairy tales, where the final goal is reached after encountering dangers beyond physical heights and a great distance away (Herrero Ruiz 146).
As the musical nears its finale, Sondheim challenges his characters and his audience to persevere through a myriad of potential obstacles, both linguistic and personal. In “No More,” the Baker has had enough of
the anomalous utterances of the Mysterious Man. “We die but we don’t,” says the Mysterious Man, prompting the Baker to demand “No more riddles,” trying to give up on the linguistic challenges imposed by the world of the woods (Sondheim & Lapine 167-168). But by continuing to engage with the complexities, he solves the Mysterious Man’s riddle, realizing his familial connection and galvanizing an end to his self-defeating inclination. He sings “No more giants / waging war … how do you ignore / all the witches / all the curses / all the wolves, all the lies…” asserting his conviction to take on the challenges that come his way (169). The audience inserts their own personal challenges in the referential position of giants, witches, curses, and wolves. The Baker refers to things within the world of the play; the audience is challenged with expanding the meaning of these words in the context of their own lives.
Sondheim’s lyrics imbued Into the Woods’ characters with defined sociolinguistic characteristics, which evolved through the journey, fulfilling a higher level of meaning that instructs the audience and demonstrates the communal evolution of language. Going together on the journey into the woods has produced new meaning for the characters and the audience. Sondheim challenges his audience to consider the impact their words and actions have on their community. It is a daunting proposition, but Sondheim assures the audience that things will come out alright, reminding the audience that “Witches can be right, / giants can be good… Just remember… someone is on your side… no one is alone” (Sondheim & Lapine 179). That’s what these fables and fairy tales are for, after all. Language continues to evolve, so be prepared to go on the journey and share your story.
The Oak Leaf | Volume 3 - Issue 1 - Spring 2022 42
Works Cited
Bennett, Michael Y. “Propositions in Theatre: Theatrical Utterances as Events.” Journal of Literary Semantics, vol. 47, no. 2, Nov. 2018, pp. 147–52. EBSCOhost, https://doi-org.ezproxy2.lsua.edu/10.1515/jls-2018-2004.
Cor, Laurence W. “Phonic Aspects of Language in the Theater.” The French Review: Journal of the American Association of Teachers of French, vol. 37, no. 1, Oct. 1963, pp. 31–40. EBSCOhost, https://search-ebscohost-com. ezproxy2.lsua.edu/login.aspx?direct=true&db=mzh&AN=0000115818&site=eds- live.
Herrero Ruiz, Javier. “At the Crossroads between Literature, Culture, Linguistics, and Cognition: ‘Life Is a Journey’ and ‘The Divided-Self’ Metaphors in Fairy Tales.” Odisea, no. 11, Mar. 2017, pp. 137–53. EBSCOhost, https://doi- org.ezproxy2.lsua.edu/10.25115/odisea.v0i11.316.
Jasna, Žmak. “Linguistics, Poetics, Theater and Drama.” Zbornik Radova Akademije Umetnosti, vol. 2019, no. 7, Jan. 2019, pp. 147–57. EBSCOhost, https://search-ebscohost-com.ezproxy2.lsua.edu/login.aspx?direct=true&db=edsdoj&AN=edsdoj.5deddf010c5347b8afb920ae19b7d5e4&site=eds-live.
Rowe, Bruce M, and Diane P. Levine. A Concise Introduction to Linguistics, 2018.
Sondheim, Stephen, and James Lapine. Into the Woods. Music Theatre International, 1987.
Sondheim, Stephen. Look, I Made a Hat: Collected Lyrics (1981-2011) With Attendant Comments, Amplifications, Dogmas, Harangues, Digressions, Anecdotes and Miscellany Alfred A. Knopf, 2011.
Symonds, Dominic. “The Story of Oh: The Aesthetics and Rhetoric of a Common Vowel Sound.” Studies in Musical Theatre, vol. 2, no. 3, Dec. 2008, pp. 245–59. EBSCOhost, https://doi-org.ezproxy2.lsua.edu/10.1386/ smt.2.3.245/1.
“Wife, V. (3).” Dictionary.com, 2022, https://www.dictionary.com/browse/wife.
The Oak Leaf | Volume 3 - Issue 1 - Spring 2022 43
Sex Addiction in Men Who Have Sex With Men
Austin Souphanthalop
Abstract
This review investigates sex addiction in men who have sex with men (MSM). In 1980, a year before the United States declared AIDS a pandemic, the Diagnostic and Statistical Manual of Mental Disorders III (DSM - III) recognized compulsive sexual behaviors as a symptom in medical diagnoses. Nine years later, the International Statistical Classification of Diseases and Related Health Problems presented ‘unspecified psychosexual disorder’ in ICD-9-CM, an edition published specifically for the United States. This review provides an overview of data gathered on sex addiction in the United States from 1980 to 2021. Results showed men who have sex with men are more likely to be affected by compulsive sexual behaviors. Men who have sex with men, on average, reported higher rates of sex addiction compared to the general population. In concurrence with negative core beliefs, societal perceptions and prejudice toward men who have sex with men revealed barriers MSM encounter when recovering from compulsive sexual behaviors. Addressing preconceived notions of sexuality (whether it is an indirect or direct effort to diminish the sexuality of men who have sex with men) contributes to the health and recovery of sex addiction in MSM.
Keywords: sex addiction, compulsive sexual behavior, men who have sex with men, gay, minority health, Sexaholics Anonymous
In 1989, the International Statistical Classification of Diseases and Related Health Problems, 9th Revision, Clinical Modification introduced “Unspecified Psychosexual Disorders” (World Health Organization, 1979). This categorization paralleled to diagnosis of “Paraphilic and Nonparaphilic Sexual Behaviors” in the Diagnostic and Statistical Manual of Mental Disorders III (American Psychiatric Association, 1980). Leading experts in the field of Psychiatry along with the HIV pandemic of 1981, raised attention regarding compulsive sexual behavior, also known as sex addiction, hypersexuality, excessive sexuality, or
problematic sexual behavior, specifically in men who have sex with men (MSM). Psychologists categorized the condition as increasing destructive preoccupations with sexual thoughts, cravings, compulsions, and behaviors negatively impacting daily functioning and quality of life (Carnes, 1992; Derbyshire & Grant, 2015). The attitudes and behaviors toward men who have sex with men embedded cultural mores and values in the context of society (heterosexuality, monogamy, marital sex, intermarital sex, and more) and resulted in negative fundamental beliefs and philosophical relationships in MSM. The early experiences of rejection or isolation, in combination with the sexual
The Oak Leaf | Volume 3 - Issue 1 - Spring 2022 44
response to negative moods, developed paradoxical mood-sexuality relationships that disproportionately affect the formation and rehabilitation of sex addiction in men who have sex with men (Bancroft & Vukadinovic, 2004).
Following the Gay Liberation Front of 1969, sexual indoctrination rode to popularity as a dangerous ideology that targeted LGBTQI+ populations. Cultural trends defined the acceptability of sexual behaviors central to the conservative sexual morality of the New Right , a political group that composed of religious organizations such as Moral Majority, Christian Broadcasting Network, and Praise The Lord and opposed issues such as abortion, homosexuality, and the Equal Rights Amendment (Encyclopedia Britannica, n.d.). In combination with religious Christian leaders and conservative bigwigs, the New Right created a narrative that believed men who have sex with men (MSM) contributed to downfall of society (Independence Hall Association, n.d.). Strongly supporting the presidency of right-wing candidates like Ronald Reagan, the New Right became the most influential group in the Republican party and implemented challenges to sexual liberalism (Independence Hall Association, n.d.). Examples included illegal abortion, abstinence in sex education, and sexual discrimination. Within a year of Reagan’s presidency, sex addicts and men who have sex with men became symbols of “dangerous, immoral, and out-of-control sexuality” (Irvine, 1995). Political conservatives and religious fundamentalists called for traditional values such as heterosexuality in reaction to the rise of LGBTQ+ identifying individuals Marty & Appleby, 1997). While activists created extensive efforts in the general acceptance of homosexuality during the civil rights era, preconceived notions regarding the identity of queer people arose as a result of the AIDS epidemic of 1981, and society associated sexual minorities, specifically men who have sex with men, with promiscuous behaviors, volitional impairment, and sexual perversion (Irvine, 1995; Ruel & Campbell, 2006). The emergence of HIV reinforced stigma and prejudice in people who held traditional values regarding sexuality. With the term “gay plague”
emerging in 1986, the pandemic “significantly increased intolerance towards the civil rights of homosexuals and the morality of homosexuality” (Ruel & Campbell, 2006). The disease galvanized the essential beliefs of traditionalists while criticizing the unconventional sexuality of men who have sex with men (Ruel & Campbell, 2006). Encouraged by fundamentalists, the moral crusade of sexual regulation pathologized AIDS due to men who have sex with men’s “unethical” behavior (Irvine, 1995).
Society’s perspective on homosexuality disproportionately affects the health of men who have sex with men (MSM). As described in the Minority Stress Theory, society’s generalization and stigma of sexual minorities place negative health consequences and disparities on men who have sex with men (Meyer, 1995). When researchers compared men who have sex with men to the general population, they found higher rates of sexual compulsivity in MSM (Makadon et al., 2015). Men who have sex with men also face higher rates of other psychological disorders; researchers have associated sexual compulsivity with this increase in mental health disorders—specifically mood disorders, anxiety disorders, and substance use disorders—and personality disorders. The comorbidity of mental health disorders and sex addiction presented 64% to 81%, while personality disorders presented 41% to 46% (Parsons et al., 2012). The harmful belief cycle of individuals affected by these disorders exhibited similarities to the psychological symptoms of sex addicts in men who have sex with men: “low self-esteem, loneliness, problems with intimacy, thrill-seeking behavior, social anxiety, social skills impairment, guilt, and impulse control problems” (Makadon et al., 2015). These feelings resonate with many men who have sex with men due to the internalized and externalized sentiments regarding homosexuality (Meyer, 1995).
Researchers found that the perception of sexual experiences as positive or negative develops at an early age and later serves as behavioral attitudes concerning sexuality and sexual activities (Kar et al., 2015). Though many men who have sex with
The Oak Leaf | Volume 3 - Issue 1 - Spring 2022 45
men (MSM) reported a history of covert childhood emotional abuse, researchers suggest that sex addiction stems from underlying psychological problems such as emotional neglect in early life (Efrati & Gola, 2018; Weiss, 2012). Aversive childhood experiences (e.g., societal rejection, homophobic violence, and emotional neglection) predispose men who have sex with men to negative relationships with sex and ineffective coping mechanisms (Bauserman & David, 1996). The conflict and anxiety regarding sexual orientation and societal homophobia deterred men who have sex with men from a healthy belief cycle. Societal means to dehumanize and regulate the sexuality of men who have sex with men increased and led MSM to believe they are unworthy of love. These oppressive expressions become ingrained in the thought process of men who have sex with men and manifest into four core beliefs in sex addicts: “1. I am an unworthy person. 2. No one will love me as I am. 3. People will never meet my needs. 4. The immediate effects of my addiction are my most important need (Carnes, 1992). During the peak of HIV, fundamentalists and drug administrators prescribed restrictive sexual norms and denied access to healthcare to many men who have sex with men and sex addicts (Makadon et al., 2015). Discrimination and legislation deprived people with AIDS, specifically gay individuals, of fundamental human rights (Ruel & Campbell, 2006). This neglection and inequality reinforced and galvanized the painful belief cycle of men who have sex with men.
A recent study indicated how social isolation suppressed “the release of several neurotransmitters like dopamine, serotonin, adrenaline, gamma-aminobutyric acid (GABA), and glutamate, which reduced ‘happiness’ and increased psychological distress or mental illness” (Wang, 2020). Specifically, gay men who experienced less personal support viewed themselves as ‘feminine’ and who were less engaged with society showed higher criteria for depression and anxiety diagnoses (Prestige, 2018). To counter this imbalance of “happy” chemicals, many men who have sex with men (MSM) endorse the use of drugs and sex as a coping mechanism to “tranquilize themselves from the unpleasant aspects of
a depressed mood state” (Reid et al., 2009). It allows them to disassociate their minds from reality and avoid negative feelings about themselves. Though researchers indicated the reuptake of neurotransmitters through sexual behaviors, the individuals’ need for validation and affection would only be temporarily satisfied (Miner & Munns, 2021; Parsons et al., 2007). The constant chase for happiness among men who have sex with men may contribute to unsustainable and ineffective coping mechanisms (Bauserman & David, 1996).
Compared to other demographics, men who have sex with men (MSM) displayed more sexual partners and more symptoms of depression (Lee et al., 2017). Though the availability of sex in the gay community endorses the need for unsustainable and distant sex through cruising locations, the salient and sexual cultural phenomenon does not present itself in women in the LGBTQ+ community or in the mental health of women in the LGBTQ+ (Kelly et al., 2009). Paired with the mental health of gay men, treating sex as a physical and emotional need rather than a form of intimacy may create an unhealthy belief cycle in men who have sex with men. It reinforces the ideas presented in the core beliefs of a sex addict: I am unworthy, no one will accept me, people will not meet my needs, and the temporary effects of sex satisfy my immediate needs (Carnes, 1992). By achieving a temporary “high” through sex, men who have sex with men may diminish these core beliefs and negative attitudes associated with sexual identity. Apps like Scruff, Grindr, and Squirt make it challenging to meet gay men as they idolize the practice of unprotected and compulsive sex and reinforce the unhealthy aspects of gay culture. Unaccepted by and disconnected from society, family, and the gay community, lack of acceptance fuels the men who have sex with men’s belief that they are unworthy of an intimate relationship and that their relationships with others will never be enough (Carnes, 1992). Men who have sex with men who suffer from sex addiction may not come to terms with their behaviors and may disregard the need for efficient coping mechanisms.
While external and internal stimuli reinforce the belief
The Oak Leaf | Volume 3 - Issue 1 - Spring 2022 46
cycle of sex addicts, societal homophobia and sexual guilt deter men who have sex with men (MSM) from receiving adequate treatment for hypersexuality (Salas, 2017). Treatment programs are often based on spiritual experiences and teachings and may discourage the typical men who have sex with men, as many religious teachings condemn the behaviors of samesex relationships (Furman, 2010). The most common recovery program for addiction is the 12-Steps Program (Carnes, 1992). This program encourages sex addicts to realize their compulsive behaviors by redefining their relationship with themselves and a higher power. Although this may come easier to heteronormative identities, men who have sex with men sex addicts may have trouble deconstructing these self-concepts and reconstructing a healthy relationship with themselves and a higher power, as years of hate and prejudice are ingrained into the harmful belief cycle (Sex Addicts Anonymous, 2009).
For decades, the push against sexual equality and liberation embedded harmful beliefs in men who have sex with men (MSM) and other individuals in the LGBTQ+ community. With the loss of many people to the HIV epidemic, men who have sex with men faced innumerable hardships such as social isolation, emotional guilt, and economic discrimination. Shortly after the peak of the AIDS epidemic, psychologists categorized problematic sexual behaviors in the ICD9-CM and DSM-III, and political conservatives and religious fundamentalists popularized the construct of a more “moral and correct” sexuality to dehumanize the presence of sexual diversity and criticize the morality of sexual minorities (Marty & Appleby, 1997). These social intolerances resulted in significant mental health disparities and reinforced unhealthy thought processes in men who have sex with men, disposing these individuals to ineffective coping mechanisms such as drugs and sex (Bauserman & David, 1996). Compared to the general population, men who have sex with men reported higher symptoms of mental illnesses, use of drugs, and use of sexual outlets (Lee, 2017; Prestage et al., 2018). Though these ineffective coping mechanisms temporarily elevate the reuptake of neurotransmitters
that decrease psychological distress and increase “happiness,” individuals may find themselves in an unsustainable lifestyle (Wang, 2020). In particular, it is difficult for men who have sex with men to establish healthy coping mechanisms through their communities as the gay community endorses the use of sex and drugs and the 12-step program incorporates a spiritual approach to healing. Although fear deters many individuals from receiving help, society must provide individuals with a safe and loving environment that allows people to better themselves and establish a community.
The Oak Leaf | Volume 3 - Issue 1 - Spring 2022 47
REFERENCES
American Psychiatric Association. (1980). Diagnostic and Statistical Manual of Mental Disorders (3rd ed.)
Bancroft, J., & Vukadinovic, Z. (2004). Sexual addiction, sexual compulsivity, sexual impulsivity, or what? Toward a theoretical model. The Journal of Sex Research, 41(3), 225–234. https://doi. org/10.1080/00224490409552230
Carnes, P. (1992). Out of the Shadows: Understanding Sexual Addiction. Hazelden Publishing.
Derbyshire, K. L., & Grant, J. E. (2015). Compulsive sexual behavior: A review of the literature. Journal of Behavioral Addictions, 4(2), 37–43. https://doi.org/10.1556/2006.4.2015.003
Encyclopædia Britannica, inc. (n.d.). New right. Encyclopædia Britannica. Retrieved October 1, 2022, from https://www.britannica.com/topic/New-Right
Efrati, Y., & Gola, M. (2018). Compulsive sexual behavior: A twelve-step therapeutic approach. Journal of Behavioral Addictions, 7(2), 445–453. https://doi.org/10.1556/2006.7.2018.26
Furman, R. (2010). Men, Compulsive Disorders, and addictions. Social Work Practice with Men at Risk, 257–276. https://doi.org/10.7312/furm14380-014
Independence Hall Association. (n.d.). The New Right. ushistory.org. Retrieved September 23, 2022, from https:// www.ushistory.org/us/58e.asp
Irvine, J. M. (1995). Reinventing Perversion: Sex Addiction and Cultural Anxieties. Journal of the History of Sexuality, 5(3), 429–450. http://www.jstor.org/stable/4617181
Kar, S. K., Choudhury, A., & Singh, A. P. (2015). Understanding normal development of adolescent sexuality: A bumpy ride. Journal of Human Reproductive Sciences, 8(2), 70. https://doi.org/10.4103/0974-1208.158594
Kelly, B. C., Bimbi, D. S., Nanin, J. E., Izienicki, H., & Parsons, J. T. (2009). Sexual compulsivity and sexual behaviors among gay and bisexual men and Lesbian and bisexual women. Journal of Sex Research, 46(4), 301–308. https://doi.org/10.1080/00224490802666225
Lee, C., Oliffe, J. L., Kelly, M. T., & Ferlatte, O. (2017). Depression and suicidality in gay men: Implications for health care providers. American Journal of Men’s Health, 11(4), 910–919. https://doi. org/10.1177/1557988316685492
Makadon, H. J., Mayer, K. H., Potter, J., & Goldhammer, H. (2015). The Fenway Guide to Lesbian, Gay, Bisexual, and Transgender Health. American College of Physicians.
Marty, M. E., & Appleby, R. S. (1997). Fundamentalisms and Society: Reclaiming the Sciences, the Family, and
The Oak Leaf | Volume 3 - Issue 1 - Spring 2022 48
Education. University of Chicago Press.
Meyer, I. H. (1995). Minority Stress and Mental Health in Gay Men. Journal of Health and Social Behavior, 36(1), 38–56. https://doi.org/10.2307/2137286
Miner, M. H., & Munns, R. (2021). Psychological treatments for paraphilias and compulsive sexual behavior. Sexual Deviance, 253–267. https://doi.org/10.1002/9781119771401.ch16
Parsons, J. T., Grov, C., & Golub, S. A. (2012). Sexual compulsivity, co-occurring psychosocial health problems, and HIV risk among gay and bisexual men: Further evidence of a syndemic. American Journal of Public Health, 102(1), 156–162. https://doi.org/10.2105/AJPH.2011.300284
Parsons, J. T., Kelly, B. C., Bimbi, D. S., Muench, F., & Morgenstern, J. (2007). Accounting for the social triggers of sexual compulsivity. Journal of Addictive Diseases, 26(3), 5–16. https://doi.org/10.1300/j069v26n03_02
Prestage, G., Hammoud, M., Jin, F., Degenhardt, L., Bourne, A., & Maher, L. (2018). Mental health, drug use and sexual risk behavior among gay and bisexual men. International Journal of Drug Policy, 55, 169–179. https://doi. org/10.1016/j.drugpo.2018.01.020
Reid, R. C., Carpenter, B. N., & Lloyd, T. Q. (2009). Assessing psychological symptom patterns of patients seeking help for hypersexual behavior. Sexual and Relationship Therapy, 24(1), 47–63. https://doi. org/10.1080/14681990802702141
Ruel, E., & Campbell, R. T. (2006). Homophobia and HIV/AIDS: Attitude change in the face of an epidemic. Social Forces, 84(4), 2167–2178. https://doi.org/10.1353/sof.2006.0110
Salas, M. (2017). ACA Counseling Corner Blog. ACA (WEBusage). Retrieved September 23, 2022, from https:// www.counseling.org/news/aca-blogs/aca-counseling-corner/aca-member-blogs/2017/03/06/sexual-addictionissues-homophobia-and-gay-men
Sex Addicts Anonymous. (2009). Sex addicts anonymous.
Weiss, R. (2012, September). Sexual Addiction, Hypersexual Disorder and the DSM-5: Myth or Legitimate Diagnosis? The Magazine for Addiction Professionals.
World Health Organization. (1979). The International Classification of Diseases, 9th Revision, Clinical Modification: ICD-9-CM.
Yang, A. S. (1997). Trends: Attitudes Toward Homosexuality. The Public Opinion Quarterly, 61(3), 477–507. http://www.jstor.org/stable/2749583
The Oak Leaf | Volume 3 - Issue 1 - Spring 2022 49